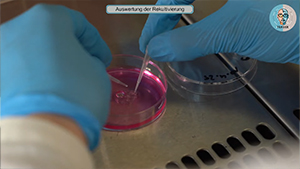
Vorbereitung 3D Druck Newsbild

KI bzw. Künstliche Intelligenz hat das Potenzial, die berufliche Bildung zu verändern. Derzeit sind Ausbilder/-innen darauf nicht vorbereitet. Das richtige Lernen mit und über KI ist dabei essenziell, insbesondere im Hinblick auf die technischen und pädagogischen Möglichkeiten.
Die betrifft insbesondere den Einsatz von Avataren zur Einbindung in die praktische berufliche Ausbildung. Ein Avatar ist eine digitale Darstellung einer realen Person und kann durch KI generiert sowie interaktiv und intelligent gemacht werden. Damit eröffnen sich neue Möglichkeiten des assistierten Einsatzes von KI und Avataren als Bildungstechnologie. Dies hat das Potenzial, Ausbilder/-innen bei repetitiven Aufgaben zu entlasten sowie Auszubildende individueller zu unterstützen.
Das transnationale Projekt „TEASER – The teacher as an avatar in vocational education and training” wird Lehr- und Lerninhalte für den Einsatz von KI und Avataren in der praktischen beruflichen Bildung für die Bereiche der Chemie, Biologie, IT und der Mechatronik entwickeln, testen, evaluieren sowie transferieren. Dies erfolgt im Hinblick auf die Unterstützung des digitalen Transformationsprozesses in den beteiligten Einrichtungen sowie der Umsetzung modernisierter Ausbildungsordnungen.
Den vollständigen Leitfaden mit allen Details zu Methoden und praktischen Anwendungen können Sie einsehen, indem Sie auf das Bild klicken, um das PDF-Dokument zu öffnen.
WP3 Lehr- und Lernszenarien
Lernszenario 1 / Biologie - Einführung in die Zellkultur und Erhaltung von Zelllinien
 Lernvideo Biologie - Definition L929 Zellen Auftauen und Ansetzen
Lernvideo Biologie - Definition L929 Zellen Auftauen und Ansetzen
In diesem Video erfährst Du zunächst, was die Zelllinie L-929 ist und welche Eigenschaften sie auszeichnet.
Im Anschluss zeige ich Dir Schritt für Schritt, wie frisch angelieferte L-929-Zellen aufgetaut und angesetzt werden.
Dabei lernst Du, worauf beim Umgang mit tiefgefrorenen Zellkulturen zu achten ist und wie die Zellen optimal für das weitere Wachstum vorbereitet werden.
Sehen wir uns nun an, wie Sie sicher und effizient mit der Zelllinie L-929 arbeiten.
Hier gehts zum Video

 Lernvideo Biologie - Sicheres Arbeiten an der Sterilwerkbank
Lernvideo Biologie - Sicheres Arbeiten an der Sterilwerkbank
In diesem Lernvideo wird die Vermittlung von Arbeitssicherheitsregeln im Umgang mit den Sterilwerkbänken gezeigt.
Hier gehts zum Video
 Lernvideo Biologie - Sicheres Arbeiten am Autoklaven
Lernvideo Biologie - Sicheres Arbeiten am Autoklaven
Das gezeigte Video beleuchtet unser Szenario aus dem biologischen Labor, das speziell die Vermittlung von Arbeitssicherheitsregeln im Umgang mit dem Autoklaven in den Fokus rückt.
Hier gehts zum Video
 Lernvideo Biologie - Passagieren der Zelllinie L-929
Lernvideo Biologie - Passagieren der Zelllinie L-929
In diesem Video erfährst Du Schritt für Schritt wie das Passagieren der Zelllinie L-929 erfolgt.
Du siehst zunächst, wie Arbeitsplatz und Arbeitsmittel unter der Sterilwerkbank vorbereitet werden.
Danach wird gezeigt, wie das alte Medium entfernt und die Zellen mit PBS gewaschen werden.
Anschließend folgen das Abtrypsinieren und die morphologische Kontrolle unter dem Mikroskop, bevor das Trypsin neutralisiert und die Zellen zentrifugiert werden.
Im nächsten Abschnitt erfährst Du, wie das Medium mit Trypsin abgenommen, frisches Medium hinzugegeben und die Kulturflaschen auf insgesamt fünf Milliliter aufgefüllt werden.
Zum Abschluss geht es um die Lagerung der Zellen nach der Passage, eine erneute morphologische Kontrolle sowie die Abschluss- und Reinigungsmaßnahmen unter der Sterilwerkbank.
Hier gehts zum Video
 Lernvideo Biologie - Mediumwechsel und Zellzählung
Lernvideo Biologie - Mediumwechsel und Zellzählung
In diesem Lernvideo wird die Zellzählung mit der Neubauer-Zählkammer gezeigt und erläutert.
Dabei sehen Sie, wie vor der Zählung zunächst ein Mediumwechsel durchgeführt und anschließend die Zellen für die Analyse vorbereitet werden.
Hier gehts zum Video
Lernszenario 2 / Biologie - Biomaterialien und 3D-Biodruck in der Zellkultur
 Lernvideo Biologie - Herstellung Alginattinte (3D-Biodruck)
Lernvideo Biologie - Herstellung Alginattinte (3D-Biodruck)
Im folgenden Lernvideo werden zuerst die Geräte und die Chemikalien für die Herstellung einer Alginattinte vorgestellt. Danach wird Schritt für Schritt erklärt, wie die Alginattinte hergestellt wird.
Hier gehts zum Video
 Lernvideo Biologie - Herstellung Gelatinesuspension (3D-Biodruck)
Lernvideo Biologie - Herstellung Gelatinesuspension (3D-Biodruck)
In der folgenden Videoanleitung werden zuerst die Geräte und die Chemikalien für die Herstellung einer Gelatinesuspension vorgestellt. Danach wird Schritt für Schritt erklärt, wie die Gelatinesuspension hergestellt wird.
Hier gehts zum Video

 Lernvideo Biologie - Vorbereitung und 3D-Biodruck
Lernvideo Biologie - Vorbereitung und 3D-Biodruck
Erfahren Sie in diesem Lernvideo wie die Vorbereitung der Gelatinesuspension und der Alginattinte erfolgt und welche Einstellungen am 3D-Biodrucker vorgenommen werden müssen. Abschließend wird der 3D-Druckprozess gezeigt.
Hier gehts zum Video

 Lernvideo Biologie - Hydrogelmodifikation und Rekultivierung
Lernvideo Biologie - Hydrogelmodifikation und Rekultivierung
Willkommen zu unserem Pilottest!
In diesem Video sehen Sie den ersten Versuch, Alginat-Objekte mit der Zelllinie L929 zu bestücken. Das Ziel: herauszufinden, ob Zellen auf einem 3D-gedruckten Alginat-Objekt wachsen können.
Dazu wurden drei Varianten getestet – Alginat eingelegt in Poly-L-Lysin, in Kollagen sowie unbehandelt. Nach der Inkubation wurden die Zellen auf die jeweiligen Proben aufgetragen, um Unterschiede im Zellwachstum zu beobachten.
Am Ende des Videos gibt es eine kurze Auswertung, wie sich die Rekultivierung auf den verschiedenen Modifizierungen optisch gezeigt hat.
Hier gehts zum Video

Lernszenario 3 / Chemie - Visualisierung der LC2030
 Lernvideo Chemie - Visualisierung der LC2030
Lernvideo Chemie - Visualisierung der LC2030
In diesem Lernvideo werden die Grundlagen zur Steuerungs- und Regelungstechnik speziell für die Visualisierung der LC2030-Ausbildungsanlage vermittelt.
Hier gehts zum Video

Lernszenario 4 / Chemie - Dreipunktkalibrierung an der LC2030
 Lernvideo Chemie - Dreipunktkalibrierung der LC2030
Lernvideo Chemie - Dreipunktkalibrierung der LC2030
In diesem Lernvideo werden die Grundlagen zur Steuerungs- und Regelungstechnik speziell für die Dreipunktkalibrierung der LC2030-Ausbildungsanlage vermittelt.
Hier gehts zum Video

Allgemeiner Evaluationsfragebogen zu den Lern-Szenarien 1-4

Lernszenario 5 / Cybersecurity meistern
 Phishing- und Malware-Erkennung
Phishing- und Malware-Erkennung
Willkommen zu einer Reise durch die wilde, sich ständig verändernde Welt des Internets und der Cybersicherheit. Wusstest du, dass Cyberbedrohungen häufiger vorkommen, als du denkst? Jeden Tag fallen unzählige Menschen Online-Betrügereien zum Opfer. Lass uns diese versteckten Gefahren erkunden und lernen, wie wir uns schützen können.
Click here for the video
 Verstehen und Erkennen von Cyber-Bedrohungen
Verstehen und Erkennen von Cyber-Bedrohungen
Willkommen zu "Verstehen und Erkennen von Cyberbedrohungen" auf deiner Reise zum Erlernen von Cybersicherheit! Wir werden reale Bedrohungen wie Malware und Phishing untersuchen – und lernen, die Warnzeichen rechtzeitig zu erkennen. Du wirst auch üben, mit ChatGPT wie ein Cybersicherheitsuntersucher zu kommunizieren! Wir werden lernen, zwei häufige Arten von Cyberbedrohungen zu erkennen: Malware und Phishing. Ich zeige dir für jede ein reales Beispiel, und danach gehen wir gemeinsam zu ChatGPT und lernen, wie man die richtigen Fragen stellt.
Click here for the video
 Werden wir angegriffen?!
Werden wir angegriffen?!
Lernende wenden das Gelernte an, indem sie ein realistisches Cyber-Bedrohungsszenario analysieren, mit ChatGPT interagieren, um Rat einzuholen, und ihre Handlungen in einer Gruppendiskussion begründen. Du hast bereits gelernt, Bedrohungen wie Phishing und Malware zu erkennen. Jetzt ist es an der Zeit, dein Wissen in einer realen Situation anzuwenden. Du wirst wieder mit ChatGPT interagieren, genau wie zuvor, aber diesmal musst du dein Denken erklären und Entscheidungen treffen. Lass uns diese Cyber-Instinkte testen!
Click here for the video
Lernszenario 6 / Python-Grundlagen mit Avatar
 Entfalte die Kraft von Python: Deine ersten Schritte in die Programmierung
Entfalte die Kraft von Python: Deine ersten Schritte in die Programmierung
Bist du neu im Programmieren? Möchtest du Python mit einem futuristischen Twist lernen? Dann bist du hier genau richtig! Unser interaktiver Coding-Kurs führt dich durch die Grundlagen der Python-Programmierung, unterstützt durch KI-generierte Avatare und Echtzeit-Hilfe von ChatGPT.
Click here for the video
 Python-Funktionen & Syntax-Grundlagen
Python-Funktionen & Syntax-Grundlagen
Lass uns einen kurzen Überblick darüber machen, wie Python funktioniert – und glaub mir, es ist einfacher, als du denkst.
Click here for the video
Lernszenario 7 / Professionelle Kommunikation – Feedback durch simulierten Dialog (Frau De Vries)
 Professionelle Kommunikation – Feedback durch simulierten Dialog
Professionelle Kommunikation – Feedback durch simulierten Dialog
Im Rahmen des Erasmus+ TEASER-Projekts wurde Mrs. De Vries als KI-gesteuerter Avatar entwickelt, der MBO/VET-Studierenden ermöglicht, professionelle Kommunikations- und Feedbackfähigkeiten in einer realistischen, WhatsApp-ähnlichen Chatumgebung zu üben. Das Lernszenario ist fest im 4G-Feedbackmodell (Verhalten, Gefühl, Konsequenz, Wunschverhalten) verankert und folgt einer strukturierten pädagogischen Abfolge, die aus Einführung, Ausführung, Reflexion und Abschluss besteht.
Click here for the video
Lernszenario 8 / Soziale Arbeit (Mutter Jarno)
 Soziale Arbeit (Mutter Jarno)
Soziale Arbeit (Mutter Jarno)
In dieser Lerneinheit trainieren die Auszubildenden den professionellen Umgang mit schwierigen Klientengesprächen in einer sicheren, digitalen Umgebung. Kern des Szenarios ist die Konfrontation mit einer verärgerten Mutter, die beim Abholen ihres Kindes (Jarno) aus einer Kindertagesstätte feststellt, dass dieses gebissen wurde, ohne dass sie vorab darüber informiert wurde. Die Lernenden interagieren mit einem KI-gesteuerten Avatar, um Deeskalationstechniken anzuwenden, Empathie zu zeigen und die Situation professionell aufzuarbeiten.
Click here for the video
Lernszenario 9 / Interaktiver Avatar für Sicherheit im Klassenzimmer
 Interaktiver Avatar für Sicherheit im Klassenzimmer - CNC Maschine
Interaktiver Avatar für Sicherheit im Klassenzimmer - CNC Maschine
Kerninhalt: Anweisung zum Tragen der persönlichen Schutzausrüstung (Schutzbrille, Gehörschutz, Sicherheitsschuhe).
Click here for the video
 Interaktiver Avatar für Sicherheit im Klassenzimmer - Elektrik
Interaktiver Avatar für Sicherheit im Klassenzimmer - Elektrik
Kerninhalt: Warnung vor der Bedienung mit nassen Händen oder in feuchter Umgebung.
Click here for the video
 Interaktiver Avatar für die Sicherheit im Klassenzimmer - Fablab
Interaktiver Avatar für die Sicherheit im Klassenzimmer - Fablab
Kerninhalt: Allgemeiner respektvoller Umgang mit Equipment.
Click here for the video
 Interaktiver Avatar für die Sicherheit im Klassenzimmer - Fotolab
Interaktiver Avatar für die Sicherheit im Klassenzimmer - Fotolab
Sicherer Umgang mit Kamera und Objektiven: Immer sichern, stabil aufstellen und sorgfältig behandeln.
Click here for the video
Lernszenario 10 / Teaser KI-Assistent
 Teaser KI-Assistent
Teaser KI-Assistent
Dieses Szenario stellt einen intelligenten, auf GPT basierenden Assistenten vor, der Lehrkräfte dabei unterstützt, ihre Unterrichtsstunden nach pädagogischen Best Practices und dem digitalen Kompetenzrahmen DigComp 2.2 zu bewerten. Der Assistent führt eine strukturierte Überprüfung von Unterrichtsplänen durch, erkennt fehlende Elemente, gibt Verbesserungsvorschläge und simuliert Expertenüberlegungen. Lehrkräfte interagieren mit dem GPT-Bewerter durch geführte Gespräche, strukturierte Eingaben und feedbackbasierte Beispiele. Das System ermöglicht eine schnellere, konsistentere und qualitativ hochwertigere Bewertung, insbesondere für neue Lehrkräfte oder solche, die an digitalen Transformationsprojekten beteiligt sind.
WP4 Blended Learning Kurs
Blended-Learning-Kurs

Unser Blended-Learning-Kurs „Avatar.AI course“ vermittelt Grundlagen zu KI und Avataren, deren Einsatz in der beruflichen Ausbildung, Sicherheits- und Ethikfragen sowie den pädagogischen Mehrwert von Avataren. Nach Klick auf den Kurs-Button werden Sie zu Moodle weitergeleitet, wo Sie sich anmelden oder registrieren und den Kurs in Deutsch, Griechisch, Niederländisch, Slowenisch oder Englisch absolvieren können. Nach Evaluierung erhalten Sie ein Zertifikat (Badge).Passwort für den Kurs: teaser
WP5 Promotionsaktivitäten
Podcasts
Best Practice Guide

Nutzen Sie unseren Best Practice Guide als praxisorientierte „Gebrauchsanweisung“ und wertvollen Kompass, um die digitale Transformation mit KI und Avataren erfolgreich in Ihrer Ausbildung zu verankern.
Fachartikel

Unser Projekt etabliert eine menschenzentrierte „Digital Pedagogy“, die technologische Innovationen wie KI und Avatare als digitale Assistenten zur Verstärkung menschlicher Lehr-Expertise nutzt, anstatt diese zu ersetzen. Getreu dem Grundsatz „Pädagogik vor Technologie“ befähigen wir Lehrkräfte dazu, von passiven Konsumenten zu aktiven Gestaltern der digitalen Transformation in der Berufsbildung zu werden. Erfahren Sie im vollständigen Fachartikel mehr über die wissenschaftliche Begleitung, die Überwindung der „Turing-Falle“ und die empirisch belegten Effizienzgewinne unseres Modells.
Innovation Digest - 8 Impulse für die digitale Transformation

Entdecken Sie in unserem Innovation Digest die spannendsten Highlights und Trends rund um den Einsatz von KI und Avataren in der beruflichen Bildung. Lassen Sie sich von praxisnahen Einblicken inspirieren und erfahren Sie kompakt zusammengefasst, wie Sie die digitale Transformation in Ihrer Ausbildung erfolgreich vorantreiben können.
Projektdauer:
10/23-12/25
Projektpartner:



Which problem is being solved?
AI, or artificial intelligence, has the potential to transform vocational education. Currently, trainers are not prepared for this. Learning with and about AI is essential, particularly with regard to the technological and pedagogical possibilities.
This is especially relevant for the use of avatars in practical vocational training. An avatar is a digital representation of a real person and can be generated, made interactive, and made intelligent through AI. This opens up new possibilities for the assisted use of AI and avatars as educational technologies. It has the potential to relieve trainers of repetitive tasks and to support trainees more individually.
The transnational project “TEASER – The teacher as an avatar in vocational education and training” will develop, test, evaluate, and transfer teaching and learning content for the use of AI and avatars in practical vocational education in the fields of chemistry, biology, IT, and mechatronics. This will be done with regard to supporting the digital transformation process in the participating institutions as well as implementing modernized training regulations.
How is the problem being solved?
-
Provision of a didactic guide for the learning-oriented integration of AI and avatars in practical training
-
Creation of a strategic guideline for decision-makers to promote the integration of AI and avatars into the workflow organisation of the participating institutions
-
Development, testing, evaluation, and transfer of at least eight AI- and avatar-enhanced teaching and learning scenarios in practical training
-
Sharing of the experiences gained through an online learning offering
-
Presentation of the results in formats such as webinars, podcasts, and national information events
Results:
WP2 Didactic Guidelines / Strategy Guide & Roadmaps
WP3 Teaching and Learning Scenarios
WP4 Blended Learning Course
WP5 Promotional Activities
Insights & Information
We are pleased to present you with an exclusive insight into the development of our avatar-based teaching and learning scenarios!
The TEASER project aims to develop and test at least ten tailored teaching and learning scenarios for practical vocational training, including for chemical and biological laboratory technicians.
The use of avatars:
Avatars are interactive, digital 3D representations of a real or artificial person. They can be made intelligent through the use of artificial intelligence (AI), such as chatbots (e.g., ChatGPT). Within these scenarios, for example, avatars can provide revised work instructions (generated with the help of ChatGPT).
Through the learning-oriented integration of AI and avatars, we support vocational education staff in developing and enhancing their digital competencies. Such modern, digitally supported teaching and learning methods help meet the requirements of modernised training regulations, such as the optional qualification “Digitalisation in research, development, analytics and production” for chemical and biological laboratory technicians.
Stay tuned and follow us for further insights into the digital transformation of vocational education!
News
 TEASER Final Conference 2025
TEASER Final Conference 2025
Future of Vocational Education: International TEASER Final Conference Showcases Innovative Solutions with AI and Avatars
On December 10, 2025, the ceremonial and professional highlight of the Erasmus+ project TEASER (“The teacher as an avatar in vocational education and training”) took place. The international final conference, held as an online-only event due to high demand, brought together around 50 experts from across Europe to discuss innovative approaches to the use of Artificial Intelligence (AI) and avatars in vocational education and training (VET).
The “Digital Toolbox” for Training
Under the title “Shaping the Future of VET,” the project consortium—consisting of partners from Germany, the Netherlands, Cyprus, and Slovenia—presented a comprehensive “digital toolbox.” The central objective: to empower teachers and trainers in the fields of chemistry, biology, IT, and mechatronics to meaningfully and ethically integrate AI chatbots and interactive 3D avatars into their teaching.
A core element of the project is its human-centered approach: technologies are consistently positioned as tools to enhance human expertise and relieve repetitive tasks—not as a replacement for teaching staff.
Practical Insights from Laboratory and Workshop
The conference offered fascinating insights into the learning scenarios developed by the partner countries:
-
Safety via QR Code: In Slovenia, mechatronics trainees receive safety instructions directly at hazardous machines (e.g., CNC systems) through avatars that appear on tablets or smartphones via QR code.
-
AI as a Coding Buddy: The Cypriot partner demonstrated how AI tools can support IT training in cybersecurity and Python programming as a “24/7 learning companion.”
-
Virtual Trainers in the Lab: SBG Dresden presented applications in cell culture technology and the operation of chemical systems, where avatars asynchronously explain complex process steps.
-
Didactic Evolution: The Graafschap College in the Netherlands highlighted the development from simple text-based systems to dynamic, AI-driven avatars for training social competencies.
The agenda of the final conference can be viewed here.






Sustainable Results as Open Educational Resources (OER)
After 27 months of intensive collaboration, all key results are now publicly available under a free license (CC BY-NC-SA):
A Permanent Knowledge Archive
SBG Dresden will continue to operate the official project website as a permanent digital knowledge archive even after the project ends. All materials, learning scenarios, and lip-synced subtitled learning videos will therefore remain accessible and adaptable for educational institutions across Europe.
 TEASER Project at the Building Bridges Conference 2025
TEASER Project at the Building Bridges Conference 2025
On 12 September 2025, we had the opportunity to present the TEASER project during the Coffee & Networking break at the Building Bridges Conference 2025 (a conference on the latest insights into artificial intelligence in science, industry, and everyday life) in Dresden.
The connection to the conference arose from the focus on “AI and Avatars.” We were able to demonstrate how artificial intelligence and virtual avatars open up new pathways for digital learning and training scenarios. AI-powered avatars create innovative possibilities for designing learning content in an interactive, personalised, and immersive way—an approach that enhances the quality of vocational education and training while making access to modern learning methods easier.
Participant interest was high, leading to exciting discussions about the opportunities and challenges that AI-supported avatars offer for the future of education and training.



 TEASER at the VSBI Members’ Meeting
TEASER at the VSBI Members’ Meeting
TEASER at the VSBI (Association of Saxon Educational Institutions) Members’ Meeting
On 10 September 2025, we had the opportunity to present the TEASER project at the VSBI members’ meeting. The project explores the use of AI-powered avatars, which enable new forms of teaching and learning. They offer the chance to design learning content in an interactive, personalised, and immersive way—an approach that presents exciting prospects, particularly for vocational education.
Our approach generated great interest, especially in the context of digitalisation and the shortage of skilled workers. Avatars provide educational institutions with the opportunity to develop their offerings in a future-oriented manner and to create innovative learning and training scenarios.
The presentation by Mr. Sam Toorchi Roodsari (PhD candidate at TU Dresden) on AI-based adaptive feedback, conducted in collaboration with Westermann Verlag, provided an excellent introduction and a thematic bridge to our TEASER presentation.
We were very pleased to be able to present our interim results at the members’ meeting—a valuable opportunity to share insights into the current project status and gain inspiring input from the exchange.


 Use of AI in Education at the Zukunftsdenken.Live Talk
Use of AI in Education at the Zukunftsdenken.Live Talk
On 7 June 2024, the online event “The Future of Work: Achieving Success with AI in the Team” took place—a joint format by Zukunftsdenken.Live and Q4.0 Talk. The free event, attended by around 50 participants, was part of the National Digital Day 2024 and was moderated by Franziska Boy (Regional Future Center Saxony – MIKOMI).

One of the day’s experts was Jens Hofmann, Head of Digitalisation Projects at the Saxon Education Company for Environmental Protection and Chemical Professions Dresden (SBGDD). In his keynote, he provided fascinating insights into the digital support of teaching and learning processes through the use of artificial intelligence (AI).
Hofmann first explored the different definitions and perspectives on AI. He described it as a hype tool, stochastic parrot, productivity tool, teaching and learning tool, and even a time machine. He also discussed the differences between open-source and on-premise solutions and demonstrated how these can be used effectively in educational work.

A particular focus of his presentation was the TEASER project (Teacher as an Avatar), which explores and tests the use of AI-powered avatars in vocational education. The project aims to digitally augment teachers through virtual avatars, enabling new forms of interaction, support, and knowledge transfer.
Within TEASER, linear and non-linear avatars are being developed and integrated with Learning Management Systems (LMS) for use in training. These avatars can, for example, present teaching content, answer questions, or provide individual guidance to learners. The approach combines technological innovation with didactic design, opening up new perspectives for the classroom of the future.
Hofmann emphasized that working with AI is a learnable skill and that it is crucial to empower both teachers and learners to use these new tools critically, creatively, and productively.
The event also provided participants with insights into further practical examples from industry, demonstrating how the introduction of AI in companies can be successfully implemented. Discussions included the necessary subprocesses for successful implementation and the use of AI for continuing education across various sectors.
Access the full talk here: The Future of Work: Achieving Success with AI in the Team
WP2 Didactic Guidelines / Strategy Guide & Roadmaps
Didactic Guidelines

Our new pedagogical guidelines provide well-founded approaches for the educationally meaningful and ethically responsible use of AI and avatars in modern vocational education.
You can view the complete guide with all details on methods and practical applications by clicking on the image to open the PDF document.
Strategy Guide

Our new strategy guide for decision-makers provides practical guidance for successfully embedding the digital transformation process with AI and avatars in your educational institution.
Simply click on the image to open the complete guide as a PDF.
Roadmaps

Our newly released roadmaps provide detailed strategies for the successful integration of AI and avatars into various fields of vocational education.
Simply click on the image to open the complete guide to digital transformation as a PDF.
Teaching and Learning Scenarios
Learning Scenario 1 / Biology – Introduction to Cell Culture and Maintenance of Cell Lines
 Biology Learning Video – Definition: Thawing and Seeding L929 Cells
Biology Learning Video – Definition: Thawing and Seeding L929 Cells
In this video, you will first learn what the L-929 cell line is and what characteristics define it.
Next, I will show you step by step how to thaw and seed freshly delivered L-929 cells.
You will learn what to pay attention to when handling frozen cell cultures and how to optimally prepare the cells for further growth.
Let’s now take a look at how to work safely and efficiently with the L-929 cell line.
Click here for the video

 Biology Learning Video – Safe Work at the Laminar Flow Hood
Biology Learning Video – Safe Work at the Laminar Flow Hood
This learning video demonstrates the teaching of safety rules for working with laminar flow hoods.
Click here for the video

 Biology Learning Video – Safe Work with the Autoclave
Biology Learning Video – Safe Work with the Autoclave
The video highlights our biological laboratory scenario, with a particular focus on teaching safety rules for working with the autoclave.
Click here for the video

 Biology Learning Video – Passaging the L-929 Cell Line
Biology Learning Video – Passaging the L-929 Cell Line
In this video, you will learn step by step how to passage the L-929 cell line.
First, you will see how to prepare the workspace and materials under the laminar flow hood.
Next, the video shows how to remove the old medium and wash the cells with PBS.
This is followed by trypsinization and a morphological check under the microscope, before neutralizing the trypsin and centrifuging the cells.
In the next section, you will learn how to remove the trypsin-containing medium, add fresh medium, and fill the culture flasks to a total of five milliliters.
Finally, the video covers the storage of the cells after passaging, another morphological check, and the final cleaning procedures under the laminar flow hood.
Click here for the video

 Biology Learning Video – Medium Change and Cell Counting
Biology Learning Video – Medium Change and Cell Counting
This learning video demonstrates and explains cell counting using the Neubauer counting chamber.
You will see how a medium change is performed before counting and how the cells are prepared for analysis.
Click here for the video
Learning Scenario 2 / Biology – Biomaterials and 3D Bioprinting in Cell Culture
 Biology Learning Video – Preparation of Alginate Ink
Biology Learning Video – Preparation of Alginate Ink
In the following learning video, the equipment and chemicals for preparing alginate ink are first introduced.
Next, it is explained step by step how to prepare the alginate ink.
Click here for the video
 Biology Learning Video – Preparation of Gelatin Suspension
Biology Learning Video – Preparation of Gelatin Suspension
In the following video tutorial, the equipment and chemicals for preparing a gelatin suspension are first introduced.
Next, it is explained step by step how to prepare the gelatin suspension.
Click here for the video

 Biology Learning Video – Preparation and 3D Bioprinting
Biology Learning Video – Preparation and 3D Bioprinting
In this learning video, you will learn how to prepare the gelatin suspension and alginate ink and which settings need to be made on the 3D bioprinter.
Finally, the 3D printing process is demonstrated.
Click here for the video

 Biology Learning Video – Hydrogel Modification and Re-cultivation
Biology Learning Video – Hydrogel Modification and Re-cultivation
Welcome to our pilot test!
In this video, you will see the first experiment of seeding L929 cells onto alginate objects. The goal is to determine whether cells can grow on a 3D-printed alginate object.
Three variants were tested: alginate treated with poly-L-lysine, with collagen, and untreated. After incubation, the cells were applied to the respective samples to observe differences in cell growth.
At the end of the video, there is a brief evaluation showing how re-cultivation appeared visually on the different modifications.
Click here for the video

Learning Scenario 3 / Chemistry – Visualization of the LC2030
 Chemistry Learning Video – Visualization of the LC2030
Chemistry Learning Video – Visualization of the LC2030
This learning video covers the basics of control and regulation technology, specifically for the visualization of the LC2030 training system.
Click here for the video

Learning Scenario 4 / Chemistry – Three-Point Calibration on the LC2030
 Chemistry Learning Video – Three-Point Calibration of the LC2030
Chemistry Learning Video – Three-Point Calibration of the LC2030
This learning video covers the basics of control and regulation technology, specifically for the three-point calibration of the LC2030 training system.
Click here for the video

Lernszenario 5 / Mastering Cybersecurity
 Spotting Phishing & Malware
Spotting Phishing & Malware
Welcome to a journey through the wild, ever-changing world of the internet and cybersecurity. Did you know that cyber threats are more common than you think? Every day, countless people fall victim to online scams. Let's explore these hidden dangers and learn how we can protect ourselves.
Click here for the video
 Understanding and Recognizing Cyber Threats
Understanding and Recognizing Cyber Threats
Welcome to "Understanding and Recognizing Cyber Threats" on your journey to learning cybersecurity! We will explore real threats like malware and phishing – and learn to recognize the warning signs in time. You will also practice communicating with ChatGPT like a cybersecurity investigator! We will learn to identify two common types of cyber threats: malware and phishing. I will show you a real example for each, and then we will go together to ChatGPT and learn how to ask the right questions.
Click here for the video
 Are we under attack?!
Are we under attack?!
Learners apply what they have learned by analyzing a realistic cyber threat scenario, interacting with ChatGPT for advice, and justifying their actions in a group discussion. You have already learned to recognize threats like phishing and malware. Now it is time to apply your knowledge in a real situation. You will interact with ChatGPT again, just like before, but this time you need to explain your thinking and make decisions. Let's test these cyber instincts!
Click here for the video
Lernszenario 6 / Python Basics with Avatar
 Unlock the Power of Python Your First Steps into Coding
Unlock the Power of Python Your First Steps into Coding
Are you new to programming? Do you want to learn Python with a futuristic twist? Then you've come to the right place! Our interactive coding course guides you through the basics of Python programming, supported by AI-generated avatars and real-time help from ChatGPT.
Click here for the video
 Python Functions & Syntax Basics
Python Functions & Syntax Basics
Let's take a brief look at how Python works – and believe me, it's easier than you think.
Click here for the video
Lernszenario 7 / Professional Communication – Feedback through Simulated Dialogue (Mrs. De Vries)
 Professional Communication – Feedback through Simulated Dialogue
Professional Communication – Feedback through Simulated Dialogue
As part of the Erasmus+ TEASER project, Mrs. De Vries was developed as an AI-driven avatar that enables MBO/VET students to practice professional communication and feedback skills in a realistic, WhatsApp-like chat environment. The learning scenario is firmly anchored in the 4G feedback model (Behavior, Feeling, Consequence, Desired Behavior) and follows a structured pedagogical sequence consisting of introduction, execution, reflection, and conclusion.
Click here for the video
Lernszenario 8 / Social Work (Mother Jarno)
 Social Work (Mother Jarno)
Social Work (Mother Jarno)
In this learning unit, trainees practice handling difficult client conversations professionally in a safe, digital environment. The core of the scenario involves confrontation with an upset mother who, when picking up her child (Jarno) from a daycare, discovers that the child has been bitten without being informed beforehand. Learners interact with an AI-driven avatar to apply de-escalation techniques, show empathy, and handle the situation professionally.
Click here for the video
Lernszenario 9 / Interactive avatar for classroom safety
 Interactive avatar for classroom safety - CNC Machine
Interactive avatar for classroom safety - CNC Machine
Core content: Instruction on wearing personal protective equipment (safety goggles, hearing protection, safety shoes).
Click here for the video
 Interactive avatar for classroom safety - Elektrika
Interactive avatar for classroom safety - Elektrika
Core content: Warning against operating with wet hands or in a damp environment.
Click here for the video
 Interactive avatar for classroom safety - Fablab
Interactive avatar for classroom safety - Fablab
Core content: General respectful handling of equipment.
Click here for the video
 Interactive avatar for classroom safety - Fotolab
Interactive avatar for classroom safety - Fotolab
Safe Handling of Cameras and Lenses: Always secure, place stably, and handle with care.
Click here for the video
Lernszenario 10 / Teaser AI assistant
 Teaser AI assistant
Teaser AI assistant
This scenario presents an intelligent, GPT-based assistant that helps teachers evaluate their lessons according to pedagogical best practices and the digital competence framework DigComp 2.2. The assistant conducts a structured review of lesson plans, identifies missing elements, provides improvement suggestions, and simulates expert thinking. Teachers interact with the GPT evaluator through guided conversations, structured inputs, and feedback-based examples. The system enables faster, more consistent, and higher-quality evaluations, especially for new teachers or those involved in digital transformation projects.
WP4 Blended Learning Course
Blended Learning Course

Our blended learning course “Avatar.AI course” provides fundamental knowledge about AI and avatars, their use in vocational training, security and ethical considerations, as well as the pedagogical added value of avatars.
After clicking the course button, you will be redirected to Moodle, where you can log in or register and complete the course in German, Greek, Dutch, Slovenian, or English. After completing the evaluation, you will receive a certificate (badge).
Password for the course: teaser
WP5 Promotional Activities
Podcasts
Best Practice Guide

Use our Best Practice Guide as a practical “manual” and valuable compass to successfully embed digital transformation with AI and avatars in your training programs.
specialist article

Our project establishes a human-centered “Digital Pedagogy” that uses technological innovations such as AI and avatars as digital assistants to enhance human teaching expertise rather than replace it. Following the principle of “Pedagogy before Technology,” we empower educators to evolve from passive consumers into active shapers of digital transformation in vocational education. Learn more in the full article about the scientific support, overcoming the “Turing Trap,” and the empirically proven efficiency gains of our model.
Innovation Digest – 8 Impulses for Digital Transformation

Discover the most exciting highlights and trends in the use of AI and avatars in vocational education in our Innovation Digest. Get inspired by practical insights and find out—summarized concisely—how you can successfully drive digital transformation in your training programs.
Project Duration:
10/23-12/25
Project Partners:



Ποιο πρόβλημα επιλύεται;
Η Τεχνητή Νοημοσύνη (ΤΝ) έχει τη δυνατότητα να μετασχηματίσει την επαγγελματική εκπαίδευση. Αυτή τη στιγμή, οι εκπαιδευτές/-τριες δεν είναι προετοιμασμένοι γι’ αυτό. Η σωστή εκμάθηση με και για την ΤΝ είναι απαραίτητη, ιδιαίτερα όσον αφορά τις τεχνικές και παιδαγωγικές δυνατότητες.
Αυτό αφορά ειδικά τη χρήση avatars για την ενσωμάτωσή τους στην πρακτική επαγγελματική εκπαίδευση. Ένα avatar είναι μια ψηφιακή αναπαράσταση ενός πραγματικού ατόμου και μπορεί να δημιουργηθεί μέσω ΤΝ, καθώς και να γίνει διαδραστικό και ευφυές. Αυτό ανοίγει νέες δυνατότητες για την υποβοηθούμενη χρήση της ΤΝ και των avatars ως τεχνολογία εκπαίδευσης. Έχει τη δυνατότητα να ελαφρύνει τους/τις εκπαιδευτές/-τριες από επαναλαμβανόμενες εργασίες και να υποστηρίζει τους/τις εκπαιδευόμενους/-ες με πιο εξατομικευμένο τρόπο.
Το διακρατικό έργο «TEASER – Ο δάσκαλος ως avatar στην επαγγελματική εκπαίδευση και κατάρτιση» θα αναπτύξει, θα δοκιμάσει, θα αξιολογήσει και θα μεταφέρει εκπαιδευτικό και μαθησιακό υλικό για τη χρήση της ΤΝ και των avatars στην πρακτική επαγγελματική εκπαίδευση στους τομείς της Χημείας, της Βιολογίας, της Πληροφορικής και της Μηχατρονικής. Αυτό γίνεται με στόχο την υποστήριξη της διαδικασίας ψηφιακού μετασχηματισμού στους συμμετέχοντες φορείς και την εφαρμογή εκσυγχρονισμένων κανονισμών εκπαίδευσης.
Πώς επιλύεται το πρόβλημα;
-
Παροχή διδακτικού οδηγού για την εκπαιδευτικά ουσιαστική ενσωμάτωση της ΤΝ και των avatars στην πρακτική εκπαίδευση
-
Δημιουργία οδηγού στρατηγικής για τους/τις υπεύθυνους/-ες λήψης αποφάσεων, για την προώθηση της ενσωμάτωσης της ΤΝ και των avatars στη διαδικασία λειτουργίας των συμμετεχόντων φορέων
-
Ανάπτυξη, δοκιμή, αξιολόγηση και μεταφορά τουλάχιστον 8 εκπαιδευτικών και μαθησιακών σεναρίων εμπλουτισμένων με ΤΝ και avatars στην πρακτική εκπαίδευση
-
Μεταφορά των εμπειριών σε μια διαδικτυακή μαθησιακή πλατφόρμα
-
Παρουσίαση των αποτελεσμάτων, π.χ. μέσω webinars, podcasts και εθνικών ενημερωτικών εκδηλώσεων
Αποτελέσματα:
WP2 Παιδαγωγικές Κατευθυντήριες Γραμμές / Στρατηγικός Οδηγός & Οδικοί Χάρτες
WP3 Σενάρια Διδασκαλίας και Μάθησης
WP4 Μάθημα Μικτής Μάθησης
WP5 Προωθητικές Δραστηριότητες
Εμπειρίες & Πληροφορίες
Με χαρά σας παρουσιάζουμε μια αποκλειστική ματιά στην ανάπτυξη των εκπαιδευτικών και μαθησιακών σεναρίων μας με βάση τα avatars!
Το έργο TEASER έχει στόχο την ανάπτυξη και δοκιμή τουλάχιστον 10 εξατομικευμένων εκπαιδευτικών και μαθησιακών σεναρίων για την πρακτική επαγγελματική εκπαίδευση, μεταξύ άλλων για χημικούς και βιολόγους εργαστηρίων.
Η χρήση των avatars: Τα avatars είναι διαδραστικές, ψηφιακές 3D αναπαραστάσεις ενός πραγματικού ή τεχνητού προσώπου. Μπορούν να γίνουν ευφυή μέσω της χρήσης Τεχνητής Νοημοσύνης (ΤΝ), όπως chatbots (π.χ. ChatGPT). Στο πλαίσιο αυτών των σεναρίων, τα avatars μπορούν για παράδειγμα να παρέχουν αναθεωρημένες οδηγίες εργασίας που δημιουργήθηκαν με τη βοήθεια του ChatGPT.
Με την εκπαιδευτικά ουσιαστική ενσωμάτωση της ΤΝ και των avatars, υποστηρίζουμε το προσωπικό επαγγελματικής εκπαίδευσης στην ανάπτυξη και ενίσχυση ψηφιακών δεξιοτήτων. Τέτοιες σύγχρονες, ψηφιακά υποστηριζόμενες μέθοδοι διδασκαλίας και μάθησης βοηθούν στην εκπλήρωση των απαιτήσεων εκσυγχρονισμένων κανονισμών εκπαίδευσης, όπως η επιλογή ειδικότητας «Ψηφιοποίηση στην Έρευνα, Ανάπτυξη, Αναλυτική και Παραγωγή» για χημικούς και βιολόγους εργαστηρίων.
Μείνετε συντονισμένοι και ακολουθήστε μας για περισσότερες πληροφορίες σχετικά με τον ψηφιακό μετασχηματισμό της επαγγελματικής εκπαίδευσης!
Νέα
 Τελικό Συνέδριο TEASER 2025
Τελικό Συνέδριο TEASER 2025
Το μέλλον της επαγγελματικής εκπαίδευσης: Το διεθνές τελικό συνέδριο TEASER παρουσιάζει καινοτόμες λύσεις με ΤΝ και άβαταρ
Στις 10 Δεκεμβρίου 2025 πραγματοποιήθηκε το εορταστικό και επιστημονικό αποκορύφωμα του έργου Erasmus+ TEASER («The teacher as an avatar in vocational education and training»). Το διεθνές τελικό συνέδριο, το οποίο πραγματοποιήθηκε αποκλειστικά διαδικτυακά λόγω της υψηλής ζήτησης, συγκέντρωσε περίπου 50 ειδικούς από όλη την Ευρώπη, προκειμένου να συζητήσουν καινοτόμες προσεγγίσεις για τη χρήση της Τεχνητής Νοημοσύνης (ΤΝ) και των άβαταρ στην επαγγελματική εκπαίδευση και κατάρτιση (VET).
Η «Ψηφιακή Εργαλειοθήκη» για την Κατάρτιση
Υπό τον τίτλο «Shaping the Future of VET», η κοινοπραξία του έργου — αποτελούμενη από εταίρους από τη Γερμανία, τις Κάτω Χώρες, την Κύπρο και τη Σλοβενία — παρουσίασε μια ολοκληρωμένη «ψηφιακή εργαλειοθήκη». Κεντρικός στόχος: η ενδυνάμωση εκπαιδευτικών και εκπαιδευτών στους τομείς της χημείας, της βιολογίας, της πληροφορικής και της μηχατρονικής, ώστε να ενσωματώνουν με ουσιαστικό και ηθικά υπεύθυνο τρόπο τα chatbots ΤΝ και τα διαδραστικά τρισδιάστατα άβαταρ στη διδασκαλία τους.
Βασικό στοιχείο του έργου αποτελεί η ανθρωποκεντρική του προσέγγιση: οι τεχνολογίες τοποθετούνται σταθερά ως εργαλεία ενίσχυσης της ανθρώπινης τεχνογνωσίας και αποφόρτισης από επαναλαμβανόμενες εργασίες — όχι ως υποκατάστατο του διδακτικού προσωπικού.
Πρακτικές Εφαρμογές από το Εργαστήριο και το Εργαστήριο Μηχανουργείου
Το συνέδριο προσέφερε συναρπαστικές παρουσιάσεις των σεναρίων μάθησης που αναπτύχθηκαν από τις χώρες-εταίρους:
- Ασφάλεια μέσω QR Code: Στη Σλοβενία, οι εκπαιδευόμενοι στη μηχατρονική λαμβάνουν οδηγίες ασφάλειας απευθείας σε επικίνδυνα μηχανήματα (π.χ. συστήματα CNC) μέσω άβαταρ που εμφανίζονται σε tablet ή smartphone μέσω QR code.
- Η ΤΝ ως Coding Buddy: Ο εταίρος από την Κύπρο παρουσίασε πώς τα εργαλεία ΤΝ μπορούν να υποστηρίξουν την εκπαίδευση στην κυβερνοασφάλεια και τον προγραμματισμό Python ως «24/7 μαθησιακός συνοδοιπόρος».
- Εικονικοί Εκπαιδευτές στο Εργαστήριο: Η SBG Dresden παρουσίασε εφαρμογές στην τεχνολογία κυτταροκαλλιέργειας και στη λειτουργία χημικών εγκαταστάσεων, όπου τα άβαταρ εξηγούν ασύγχρονα σύνθετα βήματα διαδικασιών.
- Διδακτική Εξέλιξη: Το Graafschap College στις Κάτω Χώρες ανέδειξε τη μετάβαση από απλά συστήματα βασισμένα σε κείμενο σε δυναμικά, καθοδηγούμενα από ΤΝ άβαταρ για την εκπαίδευση κοινωνικών δεξιοτήτων.
Το πρόγραμμα της τελικής διάσκεψης μπορείτε να το δείτε εδώ.






Βιώσιμα Αποτελέσματα ως Ανοικτοί Εκπαιδευτικοί Πόροι (OER)
Μετά από 27 μήνες εντατικής συνεργασίας, όλα τα βασικά αποτελέσματα είναι πλέον διαθέσιμα στο κοινό με ελεύθερη άδεια (CC BY-NC-SA):
Ένα Μόνιμο Αρχείο Γνώσης
Η SBG Dresden θα συνεχίσει να διατηρεί την επίσημη ιστοσελίδα του έργου ως ένα μόνιμο ψηφιακό αρχείο γνώσης ακόμη και μετά τη λήξη του έργου. Όλα τα υλικά, τα σενάρια μάθησης και τα εκπαιδευτικά βίντεο με συγχρονισμένους υπότιτλους θα παραμείνουν προσβάσιμα και προσαρμόσιμα για εκπαιδευτικά ιδρύματα σε όλη την Ευρώπη.
 Το έργο TEASER στο συνέδριο Building Bridges 2025
Το έργο TEASER στο συνέδριο Building Bridges 2025
Στις 12.09.2025 είχαμε την ευκαιρία να παρουσιάσουμε το έργο TEASER στο πλαίσιο της Coffee & Networking Pause στο συνέδριο Building Bridges 2025 στη Δρέσδη (συνέδριο για τις νεότερες εξελίξεις στην Τεχνητή Νοημοσύνη στην επιστήμη, τη βιομηχανία και την καθημερινή ζωή).
Η σύνδεση με το συνέδριο προέκυψε από την θεματική ενότητα «ΤΝ και Avatars». Κατά τη διάρκεια της παρουσίασης, δείξαμε πώς η τεχνητή νοημοσύνη και τα εικονικά avatars ανοίγουν νέους δρόμους για ψηφιακά σενάρια μάθησης και εκπαίδευσης. Μέσω avatars που υποστηρίζονται από ΤΝ δημιουργούνται καινοτόμες δυνατότητες για διαδραστική, εξατομικευμένη και εμβυθιστική παρουσίαση εκπαιδευτικού υλικού – μια προσέγγιση που βελτιώνει την ποιότητα της επαγγελματικής εκπαίδευσης και κατάρτισης και διευκολύνει την πρόσβαση σε σύγχρονες μεθόδους μάθησης.
Το ενδιαφέρον των συμμετεχόντων ήταν μεγάλο, και προέκυψαν συναρπαστικές συζητήσεις σχετικά με τις ευκαιρίες και τις προκλήσεις που προσφέρουν τα avatars που υποστηρίζονται από ΤΝ για το μέλλον της εκπαίδευσης και της κατάρτισης.



 Το έργο TEASER στη συνάντηση μελών του VSBI
Το έργο TEASER στη συνάντηση μελών του VSBI
Το έργο TEASER στη συνάντηση μελών του VSBI (Σύνδεσμος Σαξονικών Εκπαιδευτικών Ιδρυμάτων e.V.)
Στις 10.09.2025 είχαμε την ευκαιρία να παρουσιάσουμε το έργο TEASER στη συνάντηση μελών του VSBI. Το έργο διερευνά τη χρήση avatars που υποστηρίζονται από Τεχνητή Νοημοσύνη (ΤΝ), τα οποία ανοίγουν νέες μορφές μάθησης και διδασκαλίας. Προσφέρουν τη δυνατότητα να παρουσιάζεται το εκπαιδευτικό υλικό με διαδραστικό, εξατομικευμένο και εμβυθιστικό τρόπο – μια προσέγγιση που προσφέρει ιδιαίτερα ενδιαφέρουσες προοπτικές για την επαγγελματική εκπαίδευση.
Ιδιαίτερα στο πλαίσιο της ψηφιοποίησης και της έλλειψης εξειδικευμένου προσωπικού, η προσέγγισή μας προκάλεσε μεγάλο ενδιαφέρον. Τα avatars παρέχουν στα εκπαιδευτικά ιδρύματα τη δυνατότητα να αναπτύξουν τις προσφορές τους με προοπτική για το μέλλον και να δημιουργήσουν καινοτόμα σενάρια μάθησης και εκπαίδευσης.
Η ομιλία του κ. Sam Toorchi Roodsari (Υποψήφιος Διδάκτορας στο TU Dresden) για το ΤΝ-βασισμένο προσαρμοστικό feedback, σε συνεργασία με τον εκδοτικό οίκο Westermann, αποτέλεσε εξαιρετική εισαγωγή και θεματική γέφυρα για την παρουσίασή μας του TEASER.
Χαιρόμασταν πολύ που είχαμε την ευκαιρία να παρουσιάσουμε τα ενδιάμεσα αποτελέσματα του έργου στη συνάντηση μελών – μια πολύτιμη ευκαιρία να μοιραστούμε πληροφορίες για την τρέχουσα κατάσταση του έργου και να λάβουμε ενδιαφέροντα ερεθίσματα από τη συζήτηση.


 Η χρήση της Τεχνητής Νοημοσύνης στην εκπαίδευση στο Zukunftsdenken.Live-Talk
Η χρήση της Τεχνητής Νοημοσύνης στην εκπαίδευση στο Zukunftsdenken.Live-Talk
Στις 7 Ιουνίου 2024 πραγματοποιήθηκε η διαδικτυακή εκδήλωση «Το μέλλον της εργασίας: Επιτυχία με ΤΝ στην ομάδα» – μια κοινή πρωτοβουλία των Zukunftsdenken.Live και Q4.0 Talk. Η δωρεάν εκδήλωση, στην οποία συμμετείχαν περίπου 50 άτομα, αποτέλεσε μέρος της Εθνικής Ημέρας Ψηφιακής Τεχνολογίας 2024 και συντονίστηκε από τη Franziska Boy (Περιφερειακό Κέντρο Μέλλοντος Σαξονίας – MIKOMI).

Ένας από τους ειδικούς της ημέρας ήταν ο Jens Hofmann, υπεύθυνος έργων ψηφιοποίησης στη Σαξονική Εκπαιδευτική Εταιρεία για την Προστασία του Περιβάλλοντος και τα Χημικά Επαγγέλματα της Δρέσδης mbH (SBGDD). Στην εισαγωγική του ομιλία, έδωσε συναρπαστικές πληροφορίες σχετικά με την ψηφιακή υποστήριξη των διδακτικών και μαθησιακών διαδικασιών μέσω της χρήσης Τεχνητής Νοημοσύνης (ΤΝ).
Ο Hofmann ανέλυσε αρχικά τις διαφορετικές ορισμούς και προσεγγίσεις της ΤΝ. Την περιέγραψε ως εργαλείο hype, στοχαστικό παπαγάλο, εργαλείο παραγωγικότητας, εργαλείο διδασκαλίας και μάθησης και ως χρονομηχανή. Παράλληλα, αναφέρθηκε στη διαφορά μεταξύ λύσεων ανοιχτού κώδικα (Open-Source) και επιτόπιων λύσεων (On-Premise), δείχνοντας πώς μπορούν να χρησιμοποιηθούν με ουσιαστικό τρόπο στην εκπαιδευτική εργασία.

Ένας ιδιαίτερος άξονας της ομιλίας του ήταν το έργο TEASER (Teacher as an Avatar), που διερευνά και δοκιμάζει τη χρήση avatars υποστηριζόμενων από Τεχνητή Νοημοσύνη (ΤΝ) στην επαγγελματική εκπαίδευση. Στόχος του έργου είναι η ψηφιακή ενίσχυση των εκπαιδευτών μέσω εικονικών avatars, επιτρέποντας νέες μορφές αλληλεπίδρασης, υποστήριξης και μετάδοσης γνώσεων.
Στο πλαίσιο του TEASER αναπτύσσονται γραμμικά και μη-γραμμικά avatars, τα οποία ενσωματώνονται σε συνδυασμό με Συστήματα Διαχείρισης Μάθησης (LMS) στην εκπαίδευση. Αυτά τα avatars μπορούν, για παράδειγμα, να παρουσιάζουν εκπαιδευτικό περιεχόμενο, να απαντούν σε ερωτήσεις ή να συνοδεύουν τους/τις μαθητευόμενους/-ες ατομικά. Η προσέγγιση αυτή συνδυάζει τεχνολογική καινοτομία με διδακτικό σχεδιασμό και ανοίγει νέες προοπτικές για τη διδασκαλία του μέλλοντος.
Ο Hofmann τόνισε ότι η χρήση της ΤΝ είναι εκμάθηση και ότι το κύριο ζητούμενο είναι να ενδυναμωθούν τόσο οι εκπαιδευτές όσο και οι εκπαιδευόμενοι ώστε να χρησιμοποιούν τα νέα εργαλεία κριτικά, δημιουργικά και παραγωγικά.
Η εκδήλωση έδωσε επίσης στους συμμετέχοντες εικόνα από άλλα πρακτικά παραδείγματα στον επιχειρηματικό χώρο, που έδειξαν πώς η εισαγωγή της ΤΝ στις επιχειρήσεις μπορεί να υλοποιηθεί με επιτυχία. Συζητήθηκαν επίσης οι απαραίτητες υποδιαδικασίες για μια επιτυχημένη εφαρμογή και η χρήση της ΤΝ για συνεχιζόμενη εκπαίδευση σε διάφορους κλάδους.
Για να παρακολουθήσετε ολόκληρη την ομιλία: Το μέλλον της εργασίας: Επιτυχία με ΤΝ στην ομάδα
WP2 Παιδαγωγικές Κατευθυντήριες Γραμμές / Στρατηγικός Οδηγός & Οδικοί Χάρτες
Παιδαγωγικές Κατευθυντήριες Γραμμές

Οι νέες παιδαγωγικές μας κατευθυντήριες γραμμές προσφέρουν τεκμηριωμένες προσεγγίσεις για την παιδαγωγικά ουσιαστική και ηθικά υπεύθυνη χρήση της ΤΝ και των άβαταρ στη σύγχρονη επαγγελματική εκπαίδευση.
Μπορείτε να δείτε τον πλήρη οδηγό με όλες τις λεπτομέρειες για τις μεθόδους και τις πρακτικές εφαρμογές, κάνοντας κλικ στην εικόνα για να ανοίξετε το έγγραφο PDF.
Στρατηγικός Οδηγός

Ο νέος στρατηγικός μας οδηγός για τους υπεύθυνους λήψης αποφάσεων παρέχει πρακτική καθοδήγηση για την επιτυχή ενσωμάτωση της διαδικασίας ψηφιακού μετασχηματισμού με ΤΝ και άβαταρ στον οργανισμό εκπαίδευσής σας.
Απλά κάντε κλικ στην εικόνα για να ανοίξετε τον πλήρη οδηγό σε μορφή PDF.
Οδικοί Χάρτες

Οι πρόσφατα δημοσιευμένοι οδικοί μας χάρτες παρέχουν λεπτομερείς στρατηγικές για την επιτυχή ενσωμάτωση της ΤΝ και των άβαταρ σε διάφορους τομείς της επαγγελματικής εκπαίδευσης.
Απλά κάντε κλικ στην εικόνα για να ανοίξετε τον πλήρη οδηγό για τον ψηφιακό μετασχηματισμό σε μορφή PDF.
Σενάρια Διδασκαλίας και Μάθησης
Σενάριο Μάθησης 1 / Βιολογία – Εισαγωγή στην καλλιέργεια κυττάρων και διατήρηση κυτταρικών σειρών
 Βιντεομάθημα Βιολογίας – Ορισμός: Απόψυξη και προετοιμασία κυττάρων L929
Βιντεομάθημα Βιολογίας – Ορισμός: Απόψυξη και προετοιμασία κυττάρων L929
Σε αυτό το βίντεο θα μάθετε αρχικά τι είναι η κυτταρική γραμμή L-929 και ποιες ιδιότητες τη χαρακτηρίζουν.
Στη συνέχεια, θα σας δείξω βήμα προς βήμα πώς να αποψύξετε και να προετοιμάσετε τα φρέσκα παραδιδόμενα κύτταρα L-929.
Θα μάθετε επίσης σε τι πρέπει να δίνεται προσοχή κατά τη διαχείριση κατεψυγμένων κυτταρικών καλλιεργειών και πώς να προετοιμάζετε τα κύτταρα για βέλτιστη ανάπτυξη.
Ας δούμε τώρα πώς να εργαστείτε με ασφάλεια και αποτελεσματικά με την κυτταρική γραμμή L-929.
Πατήστε εδώ για να δείτε το βίντεο
Click here for the video

 Βιντεομάθημα Βιολογίας – Ασφαλής εργασία σε θάλαμο ροής (Laminar Flow Hood)
Βιντεομάθημα Βιολογίας – Ασφαλής εργασία σε θάλαμο ροής (Laminar Flow Hood)
Αυτό το βιντεομάθημα παρουσιάζει τη διδασκαλία των κανόνων ασφαλείας για την εργασία σε θαλάμους ροής (Laminar Flow Hoods).
Click here for the video

 Βιντεομάθημα Βιολογίας – Ασφαλής εργασία με τον αυτοκλάβο (Autoclave)
Βιντεομάθημα Βιολογίας – Ασφαλής εργασία με τον αυτοκλάβο (Autoclave)
Το βίντεο παρουσιάζει το σενάριο του βιολογικού μας εργαστηρίου, με ιδιαίτερη έμφαση στη διδασκαλία των κανόνων ασφαλείας για την εργασία με τον αυτοκλάβο.
Click here for the video

 Βιντεομάθημα Βιολογίας – Διαδοχική μεταφορά της κυτταρικής γραμμής L-929
Βιντεομάθημα Βιολογίας – Διαδοχική μεταφορά της κυτταρικής γραμμής L-929
Σε αυτό το βίντεο θα μάθετε βήμα προς βήμα πώς να πραγματοποιείτε διαδοχική μεταφορά της κυτταρικής γραμμής L-929.
Αρχικά, θα δείτε πώς να προετοιμάζετε τον χώρο εργασίας και τα υλικά κάτω από τον θάλαμο ροής (Laminar Flow Hood).
Στη συνέχεια, το βίντεο δείχνει πώς να αφαιρείτε το παλιό θρεπτικό μέσο και να πλένετε τα κύτταρα με PBS.
Ακολουθεί η τριψινινοποίηση (trypsinization) και έλεγχος της μορφολογίας των κυττάρων στο μικροσκόπιο, πριν την εξουδετέρωση της τριψίνης και την φυγοκέντρηση των κυττάρων.
Στο επόμενο μέρος, θα μάθετε πώς να αφαιρείτε το θρεπτικό μέσο που περιέχει τριψίνη, να προσθέτετε φρέσκο θρεπτικό μέσο και να γεμίζετε τις καλλιεργητικές φιάλες σε συνολικό όγκο πέντε χιλιοστόλιτρα.
Τέλος, το βίντεο καλύπτει την αποθήκευση των κυττάρων μετά τη διαδοχική μεταφορά, έναν ακόμη έλεγχο της μορφολογίας τους και τις τελικές διαδικασίες καθαρισμού κάτω από τον θάλαμο ροής.
Click here for the video

 Βιντεομάθημα Βιολογίας – Αλλαγή θρεπτικού μέσου και καταμέτρηση κυττάρων
Βιντεομάθημα Βιολογίας – Αλλαγή θρεπτικού μέσου και καταμέτρηση κυττάρων
Αυτό το βιντεομάθημα δείχνει και εξηγεί την καταμέτρηση κυττάρων χρησιμοποιώντας την θάλαμο καταμέτρησης Neubauer.
Θα δείτε πώς γίνεται η αλλαγή του θρεπτικού μέσου πριν από την καταμέτρηση και πώς προετοιμάζονται τα κύτταρα για την ανάλυση.
Click here for the video
Μαθησιακό σενάριο 2 / Βιολογία – Βιοϋλικά και 3D βιοεκτύπωση στην κυτταροκαλλιέργεια
 Βιντεομάθημα Βιολογίας – Προετοιμασία μελανιού αλγινικού
Βιντεομάθημα Βιολογίας – Προετοιμασία μελανιού αλγινικού
Στο επόμενο βιντεομάθημα, παρουσιάζονται αρχικά ο εξοπλισμός και τα χημικά που απαιτούνται για την προετοιμασία μελανιού αλγινικού.
Στη συνέχεια, εξηγείται βήμα προς βήμα πώς να προετοιμάσετε το μελάνι αλγινικού.
Click here for the video
 Βιντεομάθημα Βιολογίας – Προετοιμασία αιωρήματος ζελατίνης
Βιντεομάθημα Βιολογίας – Προετοιμασία αιωρήματος ζελατίνης
Στο επόμενο βιντεομάθημα, παρουσιάζονται αρχικά ο εξοπλισμός και τα χημικά που απαιτούνται για την προετοιμασία αιωρήματος ζελατίνης.
Στη συνέχεια, εξηγείται βήμα προς βήμα πώς να προετοιμάσετε το αιώρημα ζελατίνης.
Click here for the video

 Βιντεομάθημα Βιολογίας – Προετοιμασία και 3D Βιοεκτύπωση
Βιντεομάθημα Βιολογίας – Προετοιμασία και 3D Βιοεκτύπωση
Σε αυτό το βιντεομάθημα θα μάθετε πώς να προετοιμάζετε το αιώρημα ζελατίνης και το μελάνι αλγινικού και ποιες ρυθμίσεις πρέπει να γίνουν στον 3D βιοεκτυπωτή.
Τέλος, παρουσιάζεται η διαδικασία της 3D βιοεκτύπωσης.
Click here for the video

 Βιντεομάθημα Βιολογίας – Τροποποίηση υδρογέλης και επανακαλλιέργεια
Βιντεομάθημα Βιολογίας – Τροποποίηση υδρογέλης και επανακαλλιέργεια
Καλώς ήρθατε στη δοκιμή πιλοτικού προγράμματος!
Σε αυτό το βίντεο θα δείτε το πρώτο πείραμα εναπόθεσης κυττάρων L929 σε αντικείμενα αλγινικού. Ο στόχος είναι να διαπιστωθεί αν τα κύτταρα μπορούν να αναπτυχθούν πάνω σε ένα αντικείμενο αλγινικού που έχει εκτυπωθεί σε 3D.
Δοκιμάστηκαν τρεις παραλλαγές: αλγινικό επεξεργασμένο με poly-L-lysine, με κολλαγόνο και χωρίς καμία επεξεργασία. Μετά την επώαση, τα κύτταρα τοποθετήθηκαν στα αντίστοιχα δείγματα για να παρατηρηθούν οι διαφορές στην ανάπτυξη των κυττάρων.
Στο τέλος του βίντεο υπάρχει μια σύντομη αξιολόγηση που δείχνει πώς εμφανίστηκε οπτικά η επανακαλλιέργεια στις διάφορες τροποποιήσεις.
Click here for the video

Σενάριο Μάθησης 3 / Χημεία – Οπτικοποίηση της LC2030
 Βιντεομάθημα Χημείας – Οπτικοποίηση του LC2030
Βιντεομάθημα Χημείας – Οπτικοποίηση του LC2030
Αυτό το βιντεομάθημα καλύπτει τις βασικές αρχές της τεχνολογίας ελέγχου και ρύθμισης, ειδικά για την οπτικοποίηση του εκπαιδευτικού συστήματος LC2030.
Click here for the video

Σενάριο Μάθησης 4 / Χημεία – Τριπλή Βαθμονόμηση στη LC2030
 Βιντεομάθημα Χημείας – Τριπλή βαθμονόμηση του LC2030
Βιντεομάθημα Χημείας – Τριπλή βαθμονόμηση του LC2030
Aυτό το βιντεομάθημα καλύπτει τις βασικές αρχές της τεχνολογίας ελέγχου και ρύθμισης, ειδικά για την τριπλή βαθμονόμηση του εκπαιδευτικού συστήματος LC2030.
Click here for the video

Σενάριο Μάθησης 5 / Εξειδίκευση στην Κυβερνοασφάλεια
 Εντοπισμός Phishing & Κακόβουλου Λογισμικού
Εντοπισμός Phishing & Κακόβουλου Λογισμικού
Καλώς ήρθατε σε ένα ταξίδι στον άγριο και συνεχώς μεταβαλλόμενο κόσμο του διαδικτύου και της κυβερνοασφάλειας. Ξέρατε ότι οι κυβερνοαπειλές είναι πιο συχνές από ό,τι νομίζετε; Κάθε μέρα, αμέτρητοι άνθρωποι πέφτουν θύματα διαδικτυακών απάτων. Ας εξερευνήσουμε αυτούς τους κρυμμένους κινδύνους και ας μάθουμε πώς μπορούμε να προστατεύσουμε τον εαυτό μας.
Click here for the video
 Κατανόηση και Αναγνώριση των Κυβερνοαπειλών
Κατανόηση και Αναγνώριση των Κυβερνοαπειλών
Καλώς ήρθατε στο «Κατανόηση και Αναγνώριση των Κυβερνοαπειλών» στο ταξίδι σας για μάθηση της κυβερνοασφάλειας! Θα εξερευνήσουμε πραγματικές απειλές όπως κακόβουλο λογισμικό και phishing – και θα μάθουμε να αναγνωρίζουμε τα προειδοποιητικά σημάδια εγκαίρως. Θα εξασκηθείτε επίσης στην επικοινωνία με το ChatGPT σαν να είστε ερευνητής κυβερνοασφάλειας! Θα μάθουμε να αναγνωρίζουμε δύο κοινά είδη κυβερνοαπειλών: κακόβουλο λογισμικό και phishing. Θα σας δείξω ένα πραγματικό παράδειγμα για κάθε τύπο, και μετά θα πάμε μαζί στο ChatGPT για να μάθουμε πώς να κάνουμε τις σωστές ερωτήσεις.
Click here for the video
 Μας επιτίθενται;!
Μας επιτίθενται;!
Οι μαθητές εφαρμόζουν όσα έχουν μάθει αναλύοντας ένα ρεαλιστικό σενάριο κυβερνοαπειλής, αλληλεπιδρώντας με το ChatGPT για συμβουλές και δικαιολογώντας τις ενέργειές τους σε μια ομαδική συζήτηση. Έχετε ήδη μάθει να αναγνωρίζετε απειλές όπως το phishing και το κακόβουλο λογισμικό. Τώρα ήρθε η ώρα να εφαρμόσετε τις γνώσεις σας σε μια πραγματική κατάσταση. Θα αλληλεπιδράσετε ξανά με το ChatGPT, όπως προηγουμένως, αλλά αυτή τη φορά πρέπει να εξηγήσετε τη σκέψη σας και να πάρετε αποφάσεις. Ας δοκιμάσουμε αυτά τα κυβερνοενστικτα!
Click here for the video
Σενάριο μάθησης 6 / Βασικά στοιχεία Python με Avatar
 Ξεκλειδώστε τη Δύναμη της Python: Τα Πρώτα σας Βήματα στον Προγραμματισμό
Ξεκλειδώστε τη Δύναμη της Python: Τα Πρώτα σας Βήματα στον Προγραμματισμό
Είσαι νέος στον προγραμματισμό; Θέλεις να μάθεις Python με μια φουτουριστική προσέγγιση; Τότε έχεις έρθει στο σωστό μέρος! Το διαδραστικό μας μάθημα κώδικα σε καθοδηγεί στα βασικά του προγραμματισμού με Python, υποστηριζόμενο από avatar που δημιουργούνται με τεχνητή νοημοσύνη και βοήθεια σε πραγματικό χρόνο από το ChatGPT.
Click here for the video
 Βασικά Στοιχεία Συναρτήσεων & Σύνταξης στην Python
Βασικά Στοιχεία Συναρτήσεων & Σύνταξης στην Python
Ας ρίξουμε μια σύντομη ματιά στο πώς λειτουργεί η Python – και πίστεψέ με, είναι πιο εύκολο απ' ό,τι νομίζεις.
Click here for the video
Σενάριο Μάθησης 7 / Επαγγελματική Επικοινωνία – Ανατροφοδότηση μέσω Προσομοιωμένου Διαλόγου (Κα De Vries)
 Επαγγελματική Επικοινωνία – Ανατροφοδότηση μέσω Προσομοιωμένου Διαλόγου
Επαγγελματική Επικοινωνία – Ανατροφοδότηση μέσω Προσομοιωμένου Διαλόγου
Στο πλαίσιο του έργου Erasmus+ TEASER, η Κα De Vries αναπτύχθηκε ως avatar με τεχνητή νοημοσύνη που επιτρέπει στους μαθητές MBO/VET να εξασκούν δεξιότητες επαγγελματικής επικοινωνίας και ανατροφοδότησης σε ένα ρεαλιστικό περιβάλλον συνομιλίας, παρόμοιο με το WhatsApp. Το σενάριο μάθησης βασίζεται σταθερά στο μοντέλο ανατροφοδότησης 4G (Συμπεριφορά, Συναίσθημα, Συνέπεια, Επιθυμητή Συμπεριφορά) και ακολουθεί μια δομημένη παιδαγωγική ακολουθία που περιλαμβάνει εισαγωγή, εκτέλεση, αναστοχασμό και συμπέρασμα.
Click here for the video
Σενάριο Μάθησης 8 / Κοινωνική Εργασία (Μητέρα Jarno)
 Κοινωνική Εργασία (Μητέρα Jarno)
Κοινωνική Εργασία (Μητέρα Jarno)
Σε αυτή τη μαθησιακή ενότητα, οι εκπαιδευόμενοι εξασκούνται στο να χειρίζονται δύσκολες συνομιλίες με πελάτες με επαγγελματικό τρόπο σε ένα ασφαλές, ψηφιακό περιβάλλον. Ο πυρήνας του σεναρίου περιλαμβάνει μια αντιπαράθεση με μια αναστατωμένη μητέρα που, όταν παραλαμβάνει το παιδί της (Jarno) από έναν παιδικό σταθμό, ανακαλύπτει ότι το παιδί έχει δεχτεί δάγκωμα χωρίς να ενημερωθεί εκ των προτέρων. Οι μαθητές αλληλεπιδρούν με ένα avatar που υποστηρίζεται από τεχνητή νοημοσύνη για να εφαρμόσουν τεχνικές αποκλιμάκωσης, να δείξουν ενσυναίσθηση και να χειριστούν την κατάσταση με επαγγελματισμό.
Click here for the video
Σενάριο Μάθησης 9 / Διαδραστικό avatar για την Ασφάλεια στην Τάξη
 Διαδραστικό avatar για την Ασφάλεια στην Τάξη – Μηχανή CNC
Διαδραστικό avatar για την Ασφάλεια στην Τάξη – Μηχανή CNC
Κύριο περιεχόμενο: Οδηγίες για τη χρήση ατομικού προστατευτικού εξοπλισμού (γυαλιά ασφαλείας, προστασία ακοής, παπούτσια ασφαλείας).
Click here for the video
 Διαδραστικό avatar για την Ασφάλεια στην Τάξη – Ηλεκτρικό
Διαδραστικό avatar για την Ασφάλεια στην Τάξη – Ηλεκτρικό
Κύριο περιεχόμενο: Προειδοποίηση για τη λειτουργία με βρεγμένα χέρια ή σε υγρό περιβάλλον.
Click here for the video
 Διαδραστικό avatar για την Ασφάλεια στην Τάξη – Fablab
Διαδραστικό avatar για την Ασφάλεια στην Τάξη – Fablab
Κύριο περιεχόμενο: Γενικός σεβασμός στη χρήση του εξοπλισμού.
Click here for the video
 Διαδραστικό Άβαταρ για Ασφάλεια στην Τάξη – Fotolab
Διαδραστικό Άβαταρ για Ασφάλεια στην Τάξη – Fotolab
Ασφαλής Χρήση Κάμερας και Φακών: Πάντα ασφαλίζετε, τοποθετείτε σταθερά και χειρίζεστε με προσοχή.
Click here for the video
Σενάριο Μάθησης 10 / Βοηθός AI Teaser
 Βοηθός AI Teaser
Βοηθός AI Teaser
Αυτό το σενάριο παρουσιάζει έναν έξυπνο βοηθό βασισμένο στο GPT, ο οποίος βοηθά τους εκπαιδευτικούς να αξιολογούν τα μαθήματά τους σύμφωνα με τις παιδαγωγικές βέλτιστες πρακτικές και το πλαίσιο ψηφιακών δεξιοτήτων DigComp 2.2. Ο βοηθός πραγματοποιεί μια δομημένη ανασκόπηση των σχεδίων μαθήματος, εντοπίζει τα ελλείποντα στοιχεία, παρέχει προτάσεις βελτίωσης και προσομοιώνει τη σκέψη ενός ειδικού. Οι εκπαιδευτικοί αλληλεπιδρούν με τον αξιολογητή GPT μέσω καθοδηγούμενων συνομιλιών, δομημένων εισαγωγών και παραδειγμάτων βασισμένων στην ανατροφοδότηση. Το σύστημα επιτρέπει ταχύτερες, πιο συνεπείς και υψηλής ποιότητας αξιολογήσεις, ιδιαίτερα για νέους εκπαιδευτικούς ή για όσους συμμετέχουν σε έργα ψηφιακού μετασχηματισμού.
WP4 Μάθημα Μικτής Μάθησης
Μάθημα Μικτής Μάθησης

Το μάθημα μικτής μάθησης «Avatar.AI course» παρέχει βασικές γνώσεις για την ΤΝ και τα άβαταρ, τη χρήση τους στην επαγγελματική εκπαίδευση, θέματα ασφάλειας και ηθικής, καθώς και την παιδαγωγική προστιθέμενη αξία των άβαταρ.
Μετά το πάτημα του κουμπιού του μαθήματος, θα μεταφερθείτε στο Moodle, όπου μπορείτε να συνδεθείτε ή να εγγραφείτε και να ολοκληρώσετε το μάθημα στα Γερμανικά, Ελληνικά, Ολλανδικά, Σλοβενικά ή Αγγλικά. Μετά την ολοκλήρωση της αξιολόγησης, θα λάβετε ένα πιστοποιητικό (badge).
Κωδικός για το μάθημα: teaser
WP5 Προωθητικές Δραστηριότητες
Podcasts
Οδηγός Καλών Πρακτικών

Χρησιμοποιήστε τον Οδηγό Καλών Πρακτικών ως πρακτικό «εγχειρίδιο» και πολύτιμο οδηγό για την επιτυχή ενσωμάτωση του ψηφιακού μετασχηματισμού με ΤΝ και άβαταρ στα προγράμματα κατάρτισής σας.
Ειδικό Άρθρο

Το έργο μας θεσπίζει μια ανθρωποκεντρική «Ψηφιακή Παιδαγωγική», που χρησιμοποιεί τεχνολογικές καινοτομίες όπως η ΤΝ και τα άβαταρ ως ψηφιακούς βοηθούς για την ενίσχυση της ανθρώπινης διδακτικής τεχνογνωσίας αντί να την αντικαθιστούν. Ακολουθώντας την αρχή «Παιδαγωγική πριν από την Τεχνολογία», ενδυναμώνουμε τους εκπαιδευτικούς να εξελιχθούν από παθητικούς χρήστες σε ενεργούς διαμορφωτές του ψηφιακού μετασχηματισμού στην επαγγελματική εκπαίδευση. Μάθετε περισσότερα στο πλήρες άρθρο για την επιστημονική υποστήριξη, την υπέρβαση της «παγίδας Turing» και τα εμπειρικά αποδεδειγμένα οφέλη αποδοτικότητας του μοντέλου μας.
Innovation Digest – 8 Παρεμβάσεις για τον Ψηφιακό Μετασχηματισμό

Ανακαλύψτε τα πιο συναρπαστικά highlights και τις τάσεις στη χρήση της ΤΝ και των άβαταρ στην επαγγελματική εκπαίδευση στο Innovation Digest μας. Εμπνευστείτε από πρακτικές γνώσεις και μάθετε — συνοπτικά — πώς μπορείτε να προωθήσετε με επιτυχία τον ψηφιακό μετασχηματισμό στα προγράμματα κατάρτισής σας.
Διάρκεια έργου:
10/23-12/25
Εταίροι του έργου:



Kateri problem se rešuje?
UI oziroma umetna inteligenca ima potencial, da bistveno preoblikuje poklicno izobraževanje. Trenutno pa izobraževalci na to niso ustrezno pripravljeni. Učenje z umetno inteligenco in o njej je nujno, zlasti z vidika tehnoloških in pedagoških možnosti.
To je še posebej pomembno pri uporabi avatarjev v praktičnem poklicnem usposabljanju. Avatar je digitalna predstavitev resnične osebe in ga je mogoče ustvariti, narediti interaktivnega ter inteligentnega s pomočjo umetne inteligence. To odpira nove možnosti za podprto uporabo UI in avatarjev kot izobraževalnih tehnologij. Tak pristop ima potencial, da razbremeni izobraževalce ponavljajočih se nalog in hkrati omogoči bolj individualno podporo udeležencem usposabljanja.
Transnacionalni projekt »TEASER – Učitelj kot avatar v poklicnem izobraževanju in usposabljanju« bo razvijal, testiral, vrednotil in prenašal učne in izobraževalne vsebine za uporabo UI in avatarjev v praktičnem poklicnem izobraževanju na področjih kemije, biologije, IT in mehatronike. Projekt bo prispeval k podpori digitalne transformacije v sodelujočih institucijah ter k uvajanju posodobljenih izobraževalnih standardov in pravilnikov.
Kako se problem rešuje?
-
Priprava didaktičnega priročnika za učno usmerjeno vključevanje UI in avatarjev v praktično usposabljanje
-
Oblikovanje strateških smernic za odločevalce za spodbujanje vključevanja UI in avatarjev v organizacijo delovnih procesov sodelujočih institucij
-
Razvoj, testiranje, vrednotenje in prenos najmanj osmih z UI in avatarji podprtih učnih scenarijev v praktičnem usposabljanju
-
Deljenje pridobljenih izkušenj prek spletne učne ponudbe
-
Predstavitev rezultatov v oblikah, kot so spletni seminarji, podkasti in nacionalni informativni dogodki
Rezultati:
WP2 Didaktične smernice / Strateški vodnik in časovni načrti
WP3 Učni in poučevalni scenariji
WP4 Kombinirani učni tečaj
WP5 Promocijske aktivnosti
Vpogledi in informacije
Z veseljem vam predstavljamo ekskluziven vpogled v razvoj naših na avatarjih temelječih učnih in izobraževalnih scenarijev!
Projekt TEASER si prizadeva razviti in preizkusiti najmanj deset prilagojenih učnih scenarijev za praktično poklicno usposabljanje, med drugim tudi za kemijske in biološke laboratorijske tehnike.
Uporaba avatarjev:
Avatarji so interaktivne, digitalne 3D-predstavitve resnične ali umetne osebe. Z uporabo umetne inteligence (UI), kot so klepetalni roboti (npr. ChatGPT), jih je mogoče narediti inteligentne. V teh scenarijih lahko avatarji na primer zagotavljajo posodobljena delovna navodila (ustvarjena s pomočjo ChatGPT).
Z učno usmerjeno integracijo UI in avatarjev podpiramo strokovne delavce v poklicnem izobraževanju pri razvoju in krepitvi njihovih digitalnih kompetenc. Takšne sodobne, digitalno podprte učne metode pomagajo izpolnjevati zahteve posodobljenih izobraževalnih pravilnikov, kot je na primer izbirna kvalifikacija »Digitalizacija v raziskavah, razvoju, analitiki in proizvodnji« za kemijske in biološke laboratorijske tehnike.
Ostanite z nami in nas spremljajte za nadaljnje vpoglede v digitalno preobrazbo poklicnega izobraževanja!
novice
 TEASER Zaključna konferenca 2025
TEASER Zaključna konferenca 2025
Prihodnost poklicnega izobraževanja: mednarodna zaključna konferenca TEASER predstavlja inovativne rešitve z umetno inteligenco in avatarji
10. decembra 2025 je potekal slovesni in strokovni vrhunec projekta Erasmus+ TEASER („Učitelj kot avatar v poklicnem izobraževanju in usposabljanju“). Mednarodna zaključna konferenca, ki je bila zaradi velikega zanimanja izvedena izključno v spletni obliki, je združila približno 50 strokovnjakov iz vse Evrope z namenom razprave o inovativnih pristopih k uporabi umetne inteligence (UI) in avatarjev v poklicnem izobraževanju in usposabljanju (VET).
Digitalna orodjarna« za usposabljanje
Pod naslovom »Oblikovanje prihodnosti poklicnega izobraževanja« je projektni konzorcij – sestavljen iz partnerjev iz Nemčije, Nizozemske, Cipra in Slovenije – predstavil celovito »digitalno orodjarno«. Osrednji cilj: opolnomočiti učitelje in inštruktorje na področjih kemije, biologije, informatike in mehatronike za smiselno in etično vključevanje klepetalnih robotov z umetno inteligenco ter interaktivnih 3D-avatarjev v pouk.
Ključni element projekta je pristop, osredotočen na človeka: tehnologije so dosledno predstavljene kot orodja za krepitev človeškega strokovnega znanja in razbremenitev ponavljajočih se nalog – ne pa kot nadomestilo za pedagoško osebje.
Praktični vpogledi iz laboratorija in delavnice
Konferenca je ponudila zanimive vpoglede v učne scenarije, ki so jih razvile partnerske države:
-
Varnost prek QR-kode: V Sloveniji vajenci mehatronike prejemajo varnostna navodila neposredno pri nevarnih strojih (npr. CNC-sistemih) prek avatarjev, ki se prek QR-kode prikažejo na tablicah ali pametnih telefonih.
-
UI kot programerski partner: Ciprski partner je prikazal, kako lahko orodja umetne inteligence podpirajo IT-usposabljanje na področju kibernetske varnosti in programiranja v Pythonu kot »učni spremljevalec 24/7«.
-
Virtualni inštruktorji v laboratoriju: SBG Dresden je predstavil uporabo v tehnologiji celičnih kultur in pri upravljanju kemijskih sistemov, kjer avatarji asinhrono razlagajo kompleksne procesne korake.
-
Didaktična evolucija: Graafschap College na Nizozemskem je poudaril razvoj od preprostih besedilnih sistemov do dinamičnih, z umetno inteligenco podprtih avatarjev za usposabljanje socialnih kompetenc.
Program zaključne konference si lahko ogledate tukaj.





Trajnostni rezultati kot odprti izobraževalni viri (OER)
Po 27 mesecih intenzivnega sodelovanja so vsi ključni rezultati zdaj javno dostopni pod prosto licenco (CC BY-NC-SA):
Trajni arhiv znanja
SBG Dresden bo tudi po zaključku projekta še naprej upravljal uradno projektno spletno stran kot trajni digitalni arhiv znanja. Vsi materiali, učni scenariji in sinhronizirani učni videoposnetki s podnapisi bodo tako še naprej dostopni in prilagodljivi za izobraževalne ustanove po vsej Evropi.
 Projekt TEASER na konferenci Building Bridges 2025
Projekt TEASER na konferenci Building Bridges 2025
12. septembra 2025 smo imeli priložnost predstaviti projekt TEASER med odmorom za kavo in mreženje na konferenci Building Bridges 2025 (konferenca o najnovejših spoznanjih na področju umetne inteligence v znanosti, industriji in vsakdanjem življenju) v Dresdenu.
Povezava s konferenco je izhajala iz osrednje teme „UI in avatarji“. Predstavili smo, kako umetna inteligenca in virtualni avatarji odpirajo nove poti za digitalno učenje in scenarije usposabljanja. Avatarji, podprti z umetno inteligenco, ustvarjajo inovativne možnosti za oblikovanje učne vsebine na interaktiven, personaliziran in poglobljen način—pristop, ki izboljšuje kakovost poklicnega izobraževanja in usposabljanja ter hkrati olajšuje dostop do sodobnih učnih metod.
Zanimanje udeležencev je bilo veliko, kar je vodilo do vznemirljivih razprav o priložnostih in izzivih, ki jih avatarji, podprti z umetno inteligenco, ponujajo za prihodnost izobraževanja in usposabljanja.



 TEASER na sestanku članov VSBI
TEASER na sestanku članov VSBI
TEASER na sestanku članov VSBI (Združenje saskih izobraževalnih ustanov)
10. septembra 2025 smo imeli priložnost predstaviti projekt TEASER na sestanku članov VSBI. Projekt raziskuje uporabo avatarjev, podprtih z umetno inteligenco, ki omogočajo nove oblike poučevanja in učenja. Nudijo možnost oblikovanja učne vsebine na interaktiven, personaliziran in poglobljen način—pristop, ki odpira vznemirljive perspektive, zlasti za poklicno izobraževanje.
Naš pristop je vzbudil veliko zanimanje, predvsem v kontekstu digitalizacije in pomanjkanja usposobljenih kadrov. Avatarji izobraževalnim ustanovam omogočajo, da svoje ponudbe razvijajo na prihodnost usmerjen način ter ustvarjajo inovativne učne in izobraževalne scenarije.
Predstavitev gospoda Sama Toorchi Roodsarija (doktorski kandidat na TU Dresden) o adaptivni povratni informaciji, temelječi na umetni inteligenci, ki je bila izvedena v sodelovanju z založbo Westermann Verlag, je odlično uvodoma povezala temo in tvorila most do naše TEASER predstavitve.
Zelo smo bili veseli, da smo lahko na sestanku članov predstavili naše vmesne rezultate—dragocena priložnost za deljenje vpogledov v trenutni status projekta in pridobitev navdihujočih prispevkov iz izmenjave izkušenj.


 Uporaba umetne inteligence v izobraževanju na pogovoru Zukunftsdenken.Live
Uporaba umetne inteligence v izobraževanju na pogovoru Zukunftsdenken.Live
7. junija 2024 je potekal spletni dogodek „Prihodnost dela: doseganje uspeha z umetno inteligenco v timu“—skupni format Zukunftsdenken.Live in Q4.0 Talk. Brezplačnega dogodka, ki se ga je udeležilo približno 50 udeležencev, se je udeležil kot del Nacionalnega digitalnega dne 2024 in ga je moderirala Franziska Boy (Regionalni center za prihodnost Saške – MIKOMI).

Eden od strokovnjakov dneva je bil Jens Hofmann, vodja projektov digitalizacije pri Saški izobraževalni ustanovi za okoljsko zaščito in kemične poklice v Dresdenu (SBGDD). V svojem uvodnem predavanju je predstavil fascinantne vpoglede v digitalno podporo poučevanju in učnim procesom z uporabo umetne inteligence (UI).
Hofmann je najprej raziskal različne definicije in perspektive UI. Opisal jo je kot orodje hype, stohastičnega papagaja, orodje za produktivnost, orodje za poučevanje in učenje, celo kot časovni stroj. Prav tako je razpravljal o razlikah med rešitvami odprte kode in lokalno nameščenimi rešitvami ter prikazal, kako jih je mogoče učinkovito uporabljati v izobraževalnem delu.

Poseben poudarek njegove predstavitve je bil na projektu TEASER (Učitelj kot avatar), ki raziskuje in preizkuša uporabo avatarjev, podprtih z umetno inteligenco, v poklicnem izobraževanju. Projekt si prizadeva učitelje digitalno nadgraditi prek virtualnih avatarjev, kar omogoča nove oblike interakcije, podpore in prenosa znanja.
V okviru projekta TEASER se razvijajo linearni in nelinearni avatarji, ki se integrirajo z učnimi sistemi za upravljanje učenja (LMS) za uporabo v izobraževanju in usposabljanju. Ti avatarji lahko na primer predstavljajo učne vsebine, odgovarjajo na vprašanja ali nudijo individualno vodstvo učencem. Pristop združuje tehnološke inovacije z didaktičnim oblikovanjem, kar odpira nove perspektive za učilnice prihodnosti.
Hofmann je poudaril, da je delo z umetno inteligenco veščina, ki se jo je mogoče naučiti, in da je ključnega pomena, da tako učitelje kot učence opolnomočimo za kritično, ustvarjalno in produktivno uporabo teh novih orodij.
Dogodek je udeležencem ponudil tudi vpoglede v dodatne praktične primere iz industrije, ki prikazujejo, kako je mogoče uspešno uvajati umetno inteligenco v podjetjih. Razprave so vključevale potrebne podprocese za uspešno implementacijo ter uporabo umetne inteligence za nadaljnje izobraževanje v različnih sektorjih.
Dostop do celotnega pogovora tukaj: Prihodnost dela: doseganje uspeha z umetno inteligenco v timu
WP2 Didaktične smernice / Strateški vodnik in časovni načrti
Didaktične smernice

Naše nove pedagoške smernice ponujajo utemeljene pristope za pedagoško smiselno in etično odgovorno uporabo umetne inteligence (UI) in avatarjev v sodobnem poklicnem izobraževanju.
Celoten vodnik z vsemi podrobnostmi o metodah in praktičnih uporabah si lahko ogledate tako, da kliknete na sliko za odpiranje PDF-dokumenta.
Strateški vodnik

Naš novi strateški vodnik za odločevalce ponuja praktična navodila za uspešno vključitev procesa digitalne transformacije z UI in avatarji v vašo izobraževalno ustanovo.
Preprosto kliknite na sliko, da odprete celoten vodnik v PDF-obliki.
Časovni načrti (Roadmaps)

Naši nedavno objavljeni časovni načrti ponujajo podrobne strategije za uspešno integracijo UI in avatarjev v različna področja poklicnega izobraževanja.
Preprosto kliknite na sliko, da odprete celoten vodnik o digitalni transformaciji v PDF-obliki.
WP3 Učni in poučevalni scenariji
Učni in poučevalni scenariji
Učni scenarij 1 / Biologija – Uvod v celično kulturo in vzdrževanje celičnih linij
 Učni video iz biologije – Definicija: Odmrzovanje in sejanje celic L929
Učni video iz biologije – Definicija: Odmrzovanje in sejanje celic L929
V tem videu se boste najprej naučili, kaj je celična linija L-929 in katere značilnosti jo opredeljujejo.
Nato vam bom korak za korakom pokazal, kako odmrzniti in sejati sveže dostavljene celice L-929.
Naučili se boste, na kaj morate biti pozorni pri rokovanju z zamrznjenimi celičnimi kulturami in kako celice optimalno pripraviti za nadaljnjo rast.
Poglejmo si zdaj, kako varno in učinkovito delati s celično linijo L-929.
Click here for the video

 Učni video iz biologije – Varno delo pri laminarni pretokovni omari
Učni video iz biologije – Varno delo pri laminarni pretokovni omari
Ta učni video prikazuje poučevanje varnostnih pravil za delo pri laminarnih pretokovnih omarah.
Click here for the video

 Učni video iz biologije – Varno delo z avtoklavom
Učni video iz biologije – Varno delo z avtoklavom
Video izpostavlja naš biološki laboratorijski scenarij, s posebnim poudarkom na poučevanju varnostnih pravil za delo z avtoklavom.
Click here for the video

 Učni video iz biologije – Presejanje celične linije L-929
Učni video iz biologije – Presejanje celične linije L-929
V tem videu se boste korak za korakom naučili, kako presejati celično linijo L-929.
Najprej boste videli, kako pripraviti delovno mesto in materiale pod laminarno pretokovno omaro.
Nato video prikazuje, kako odstraniti star medij in oprati celice s PBS.
Sledi tripeptinizacija in morfološka kontrola pod mikroskopom, preden se tripeptin nevtralizira in celice centrifugirajo.
V naslednjem delu se boste naučili, kako odstraniti medij, ki vsebuje tripeptin, dodati svež medij in napolniti kultivne bučke do skupno pet mililitrov.
Na koncu video zajema shranjevanje celic po presejanju, še eno morfološko kontrolo ter končne postopke čiščenja pod laminarno pretokovno omaro.
Click here for the video

 Učni video iz biologije – Menjava medija in štetje celic
Učni video iz biologije – Menjava medija in štetje celic
Ta učni video prikazuje in razlaga štetje celic z uporabo Neubauerjeve štetvene komore.
Videli boste, kako se izvede menjava medija pred štetjem in kako se celice pripravijo za analizo.
Click here for the video
Učni scenarij 2 / Biologija – Biomateriali in 3D biotiskanje v celični kulturi
 Učni video iz biologije – Priprava alginatne paste
Učni video iz biologije – Priprava alginatne paste
V naslednjem učnem videu so najprej predstavljena oprema in kemikalije za pripravo alginatne paste.
Nato je korak za korakom razloženo, kako pripraviti alginatno pasto.
Click here for the video
 Učni video iz biologije – Priprava želatinske suspenzije
Učni video iz biologije – Priprava želatinske suspenzije
V naslednjem video vodiču so najprej predstavljena oprema in kemikalije za pripravo želatinske suspenzije.
Nato je korak za korakom razloženo, kako pripraviti želatinsko suspenzijo.
Click here for the video

 Učni video iz biologije – Priprava in 3D biotiskanje
Učni video iz biologije – Priprava in 3D biotiskanje
V tem učnem videu se boste naučili, kako pripraviti želatinsko suspenzijo in alginatno pasto ter katere nastavitve je treba izvesti na 3D biotiskalniku.
Na koncu je prikazan postopek 3D tiskanja.
Click here for the video

 Učni video iz biologije – Modifikacija hidrogela in ponovna kultivacija
Učni video iz biologije – Modifikacija hidrogela in ponovna kultivacija
Dobrodošli na našem pilotnem testu!
V tem videu boste videli prvi poskus sejanja celic L929 na alginatne objekte. Cilj je bil ugotoviti, ali celice lahko rastejo na 3D-tiskanem alginatnem objektu.
Preizkušene so bile tri različice: alginat, obdelan s poli-L-lizinom, s kolagenom in neobdelan. Po inkubaciji so bile celice nanesene na posamezne vzorce, da bi opazili razlike v rasti celic.
Na koncu videa je kratka ocena, ki prikazuje, kako je ponovna kultivacija vizualno izgledala pri različnih modifikacijah.
Click here for the video

Učni scenarij 3 / Kemija – Vizualizacija LC2030
 Učni video iz kemije – Vizualizacija LC2030
Učni video iz kemije – Vizualizacija LC2030
Ta učni video zajema osnove tehnologije krmiljenja in regulacije, posebej za vizualizacijo učnega sistema LC2030.
Click here for the video

Učni scenarij 4 / Kemija – Trokalibracija na LC2030
 Učni video iz kemije – Trokalibracija LC2030
Učni video iz kemije – Trokalibracija LC2030
Ta učni video zajema osnove tehnologije krmiljenja in regulacije, posebej za trokalkibracijo učnega sistema LC2030.
Click here for the video

Učni scenarij 5 / Obvladovanje kibernetske varnosti
 Prepoznavanje phishinga in zlonamerne programske opreme
Prepoznavanje phishinga in zlonamerne programske opreme
Dobrodošli na popotovanju skozi divji in nenehno spreminjajoči se svet interneta in kibernetske varnosti. Ali ste vedeli, da so kibernetske grožnje pogostejše, kot si mislite? Vsak dan nešteto ljudi postane žrtev spletnih prevar. Raziščimo te skrite nevarnosti in se naučimo, kako se lahko zaščitimo.
Click here for the video
 Razumevanje in prepoznavanje kibernetskih groženj
Razumevanje in prepoznavanje kibernetskih groženj
Dobrodošli v lekciji »Razumevanje in prepoznavanje kibernetskih groženj« na vaši poti učenja kibernetske varnosti! Raziščemo resnične grožnje, kot sta zlonamerna programska oprema in phishing – ter se naučimo pravočasno prepoznati opozorilne znake. Prav tako se boste vadili v komunikaciji s ChatGPT kot pravi preiskovalec kibernetske varnosti! Naučili se bomo prepoznati dve pogosti vrsti kibernetskih groženj: zlonamerno programsko opremo in phishing. Pokazal vam bom resničen primer za vsako, nato pa bomo skupaj šli do ChatGPT in se naučili, kako zastaviti prava vprašanja.
Click here for the video
 Ali smo pod napadom?!
Ali smo pod napadom?!
Učenci uporabijo svoje pridobljeno znanje tako, da analizirajo realistično scenarijo kibernetske grožnje, sodelujejo s ChatGPT za nasvete in utemeljujejo svoja dejanja v skupinski razpravi. Že ste se naučili prepoznavati grožnje, kot sta phishing in zlonamerna programska oprema. Zdaj je čas, da svoje znanje uporabite v resnični situaciji. Ponovno boste sodelovali s ChatGPT, kot prej, a tokrat boste morali razložiti svoje razmišljanje in sprejemati odločitve. Preizkusimo te kibernetske instinkte!
Click here for the video
Učni scenarij 6 / Osnove Pythona z avatarjem
 Odklenite moč Pythona: vaši prvi koraki v programiranje
Odklenite moč Pythona: vaši prvi koraki v programiranje
Ste novi v programiranju? Želite spoznati Python z futurističnim pridihom? Potem ste na pravem mestu! Naš interaktivni tečaj programiranja vas vodi skozi osnove Pythona, podprt z avatarji, ustvarjenimi z umetno inteligenco, in pomočjo v realnem času preko ChatGPT.
Click here for the video
 Funkcije in osnovna sintaksa Pythona
Funkcije in osnovna sintaksa Pythona
Poglejmo si na kratko, kako Python deluje – in verjemite, lažje je, kot si mislite.
Click here for the video
Učni scenarij 7 / Profesionalna komunikacija – Povratne informacije preko simuliranega dialoga (ga. De Vries)
 Profesionalna komunikacija – Povratne informacije preko simuliranega dialoga
Profesionalna komunikacija – Povratne informacije preko simuliranega dialoga
V okviru projekta Erasmus+ TEASER je bila ga. De Vries razvita kot avatar, ki ga poganja umetna inteligenca, in omogoča študentom MBO/VET, da vadijo profesionalne komunikacijske in povratne veščine v realistično zasnovanem okolju za klepet, podobnem WhatsAppu. Učni scenarij je trdno zasidran v 4G modelu povratnih informacij (vedenje, občutki, posledice, željeno vedenje) in sledi strukturiranemu pedagoškemu zaporedju, ki vključuje uvod, izvedbo, refleksijo in zaključek.
Click here for the video
Učni scenarij 8 / Socialno delo (mama Jarno)
 Socialno delo (mama Jarno)
Socialno delo (mama Jarno)
V tej učni enoti se usposabljanci učijo profesionalno obvladovati težke pogovore s strankami v varnem digitalnem okolju. Srž scenarija vključuje soočenje z razburjeno materjo, ki ob prevzemu svojega otroka (Jarno) iz vrtca odkrije, da je otrok bil ugrizen, ne da bi bila prej obveščena. Udeleženci se pogovarjajo z avatarjem, ki ga poganja umetna inteligenca, da uporabijo tehnike de-eskalacije, pokažejo empatijo in situacijo obvladajo profesionalno.
Click here for the video
Učni scenarij 9 / Interaktivni avatar za varnost v razredu
 Interaktivni avatar za varnost v razredu – CNC stroj
Interaktivni avatar za varnost v razredu – CNC stroj
Glavna vsebina: Navodila za uporabo osebne zaščitne opreme (zaščitna očala, zaščita sluha, varnostni čevlji).
Click here for the video
 Interaktivni avatar za varnost v razredu - Elektrika
Interaktivni avatar za varnost v razredu - Elektrika
Glavna vsebina: Opozorilo pred delovanjem z mokrimi rokami ali v vlažnem okolju.
Click here for the video
 Interaktivni avatar za varnost v razredu - Fablab
Interaktivni avatar za varnost v razredu - Fablab
Glavna vsebina: Splošno spoštljivo ravnanje z opremo.
Click here for the video
 Interaktivni avatar za varnost v učilnici – Fotolab
Interaktivni avatar za varnost v učilnici – Fotolab
Varno rokovanje s kamero in objektivi: Vedno zagotovite varnost, postavite stabilno in ravnajte previdno.
Click here for the video
Učni scenarij 10 / Teaser AI pomočnik
 Teaser AI pomočnik
Teaser AI pomočnik
Ta scenarij predstavlja inteligentnega asistenta, ki temelji na GPT, in pomaga učiteljem ocenjevati njihove učne ure v skladu s pedagoškimi najboljšimi praksami in okvirjem digitalnih kompetenc DigComp 2.2. Asistent izvaja strukturiran pregled učnih načrtov, prepozna manjkajoče elemente, ponudi predloge za izboljšave in simulira strokovno razmišljanje. Učitelji komunicirajo z GPT ocenjevalcem preko vodene konverzacije, strukturiranih vnosov in primerov, temelječih na povratnih informacijah. Sistem omogoča hitrejše, bolj dosledne in kakovostnejše ocene, še posebej za nove učitelje ali tiste, ki so vključeni v projekte digitalne transformacije.
WP4 Kombinirani učni tečaj
Kombinirani učni tečaj

Naš kombinirani učni tečaj „Avatar.AI course“ zagotavlja osnovno znanje o umetni inteligenci in avatarjih, njihovi uporabi v poklicnem usposabljanju, varnostnih in etičnih vprašanjih ter pedagoški dodani vrednosti avatarjev.
Ko kliknete na gumb za tečaj, boste preusmerjeni na Moodle, kjer se lahko prijavite ali registrirate in dokončate tečaj v nemščini, grščini, nizozemščini, slovenščini ali angleščini. Po dokončani evalvaciji boste prejeli potrdilo (badge).
Geslo za tečaj: teaser
WP5 Promocijske aktivnosti
Podcasts
Vodnik dobrih praks

Uporabite naš Vodnik dobrih praks kot praktičen „priročnik“ in dragocen kompas za uspešno vključevanje digitalne transformacije z UI in avatarji v vaše programe usposabljanja.
Strokovni članek

Naš projekt uvaja človeku osredotočeno „Digitalno pedagogiko“, ki uporablja tehnološke inovacije, kot so UI in avatarji, kot digitalne pomočnike za povečanje človeške pedagoške strokovnosti, ne pa kot nadomestilo zanje. Sledenje načelu „Pedagogika pred tehnologijo“ omogoča, da se izobraževalci razvijejo iz pasivnih uporabnikov v aktivne soustvarjalce digitalne transformacije v poklicnem izobraževanju. Več o znanstveni podpori, premagovanju „Turingove pasti“ in empirično dokazani povečani učinkovitosti našega modela si preberite v celotnem članku.
Innovation Digest – 8 impulzov za digitalno preobrazbo

V našem Innovation Digest odkrijte najbolj zanimive poudarke in trende pri uporabi UI in avatarjev v poklicnem izobraževanju. Navdihnite se s praktičnimi vpogledi in izvedite – na jedrnat način povzeto – kako lahko uspešno pospešite digitalno transformacijo v svojih programih usposabljanja.
Trajanje projekta:
10/23-12/25
Partnerske organizacije projekta:



Welk probleem wordt opgelost?
AI, of kunstmatige intelligentie, heeft het potentieel om het beroepsonderwijs te transformeren. Op dit moment zijn trainers hier nog niet op voorbereid. Leren met en over AI is essentieel, met name met betrekking tot de technologische en pedagogische mogelijkheden.
Dit is vooral relevant voor het gebruik van avatars in praktisch beroepsonderwijs. Een avatar is een digitale weergave van een echt persoon en kan door AI worden gegenereerd, interactief worden gemaakt en intelligent worden gemaakt. Dit opent nieuwe mogelijkheden voor het ondersteund gebruik van AI en avatars als onderwijstechnologieën. Het kan trainers ontlasten van repetitieve taken en stagiairs meer individuele ondersteuning bieden.
Het transnationale project “TEASER – The teacher as an avatar in vocational education and training” zal onderwijs- en leermateriaal ontwikkelen, testen, evalueren en overdragen voor het gebruik van AI en avatars in praktisch beroepsonderwijs in de vakgebieden chemie, biologie, IT en mechatronica. Dit gebeurt met het oog op het ondersteunen van het digitale transformatieproces in de deelnemende instellingen en het implementeren van gemoderniseerde opleidingsregelgeving.
Hoe wordt het probleem opgelost?
-
Verstrekking van een didactische gids voor de leergerichte integratie van AI en avatars in de praktische opleiding
-
Opstellen van een strategische richtlijn voor besluitvormers om de integratie van AI en avatars in de werkorganisatie van de deelnemende instellingen te bevorderen
-
Ontwikkeling, testen, evaluatie en overdracht van minimaal acht AI- en avatar-verrijkte onderwijs- en leerscenario’s in de praktische opleiding
-
Delen van de opgedane ervaringen via een online leerplatform
-
Presentatie van de resultaten in formats zoals webinars, podcasts en nationale informatiedagen
Resultaten:
WP2 Didactische Richtlijnen / Strategiegids & Roadmaps
WP3 Onderwijs- en Leerscenario’s
WP4 Blended Learning Cursus
WP5 Promotionele activiteiten
Inzichten & Informatie
We zijn verheugd u een exclusief inzicht te geven in de ontwikkeling van onze avatar-gebaseerde onderwijs- en leerscenario’s!
Het TEASER-project heeft als doel om minimaal tien op maat gemaakte onderwijs- en leerscenario’s voor praktisch beroepsonderwijs te ontwikkelen en testen, onder andere voor chemische en biologische laboratoriumtechnici.
Het gebruik van avatars:
Avatars zijn interactieve, digitale 3D-weergaven van een echt of kunstmatig persoon. Ze kunnen intelligent worden gemaakt door het gebruik van kunstmatige intelligentie (AI), zoals chatbots (bijv. ChatGPT). Binnen deze scenario’s kunnen avatars bijvoorbeeld herziene werkinstructies geven (gegenereerd met behulp van ChatGPT).
Door de leergerichte integratie van AI en avatars ondersteunen we het personeel in het beroepsonderwijs bij het ontwikkelen en verbeteren van hun digitale competenties. Dergelijke moderne, digitaal ondersteunde onderwijs- en leermethoden helpen te voldoen aan de eisen van gemoderniseerde opleidingsregelgeving, zoals de optionele kwalificatie “Digitalisering in onderzoek, ontwikkeling, analyse en productie” voor chemische en biologische laboratoriumtechnici.
Blijf op de hoogte en volg ons voor meer inzichten in de digitale transformatie van het beroepsonderwijs!
News
 TEASER Eindconferentie 2025
TEASER Eindconferentie 2025
Toekomst van het beroepsonderwijs: Internationale TEASER-eindconferentie toont innovatieve oplossingen met AI en avatars
Op 10 december 2025 vond het ceremoniële en professionele hoogtepunt van het Erasmus+-project TEASER (“De docent als avatar in beroepsonderwijs en -opleiding”) plaats. De internationale eindconferentie, die vanwege de grote belangstelling uitsluitend online werd georganiseerd, bracht ongeveer 50 experts uit heel Europa samen om innovatieve benaderingen voor het gebruik van Kunstmatige Intelligentie (AI) en avatars in het beroepsonderwijs en de beroepsopleiding (VET) te bespreken.
De “Digitale Toolbox” voor training
Onder de titel “Shaping the Future of VET” presenteerde het projectconsortium – bestaande uit partners uit Duitsland, Nederland, Cyprus en Slovenië – een uitgebreide “digitale toolbox”. Het centrale doel: docenten en trainers in de vakgebieden chemie, biologie, IT en mechatronica in staat stellen om AI-chatbots en interactieve 3D-avatars op een zinvolle en ethisch verantwoorde manier in hun onderwijs te integreren.
Een kernelement van het project is de mensgerichte benadering: technologieën worden consequent gepositioneerd als hulpmiddelen om menselijke expertise te versterken en repetitieve taken te verlichten – niet als vervanging van onderwijspersoneel.
Praktische inzichten uit laboratorium en werkplaats
De conferentie bood boeiende inzichten in de leerscenario’s die door de partnerlanden zijn ontwikkeld:
- Veiligheid via QR-code: In Slovenië ontvangen mechatronicastagiairs veiligheidsinstructies direct bij gevaarlijke machines (bijv. CNC-systemen) via avatars die via een QR-code op tablets of smartphones verschijnen.
-
AI als programmeerbuddy: De Cypriotische partner demonstreerde hoe AI-tools IT-onderwijs in cybersecurity en Python-programmering kunnen ondersteunen als een “24/7 leermaatje”.
-
Virtuele trainers in het lab: SBG Dresden presenteerde toepassingen in celkweektechnologie en de bediening van chemische systemen, waarbij avatars asynchroon complexe processtappen uitleggen.
-
Didactische evolutie: Het Graafschap College in Nederland benadrukte de ontwikkeling van eenvoudige tekstgebaseerde systemen naar dynamische, door AI aangestuurde avatars voor het trainen van sociale competenties.
De agenda van de eindconferentie is hier te bekijken.






Duurzame resultaten als Open Educational Resources (OER)
Na 27 maanden intensieve samenwerking zijn alle belangrijke resultaten nu openbaar beschikbaar onder een vrije licentie (CC BY-NC-SA):
Een permanent kennisarchief
SBG Dresden zal de officiële projectwebsite ook na afloop van het project blijven beheren als een permanent digitaal kennisarchief. Alle materialen, leerscenario’s en lipsynchroon ondertitelde leervideo’s blijven daardoor toegankelijk en aanpasbaar voor onderwijsinstellingen in heel Europa.
 TEASER-project op de Building Bridges Conferentie 2025
TEASER-project op de Building Bridges Conferentie 2025
Op 12 september 2025 kregen we de kans om het TEASER-project te presenteren tijdens de Coffee & Networking-pauze op de Building Bridges Conferentie 2025 (een conferentie over de nieuwste inzichten in kunstmatige intelligentie in wetenschap, industrie en dagelijks leven) in Dresden.
De link met de conferentie ontstond door de focus op “AI en Avatars.” We konden laten zien hoe kunstmatige intelligentie en virtuele avatars nieuwe mogelijkheden openen voor digitale leer- en trainingsscenario’s. Door AI aangedreven avatars creëren innovatieve kansen om leerinhoud op een interactieve, gepersonaliseerde en meeslepende manier vorm te geven—een aanpak die de kwaliteit van het beroepsonderwijs verbetert en tegelijkertijd de toegang tot moderne leermethoden vergemakkelijkt.
De interesse van de deelnemers was groot, wat leidde tot boeiende discussies over de kansen en uitdagingen die AI-ondersteunde avatars bieden voor de toekomst van onderwijs en opleiding.



 TEASER op de VSBI Ledenvergadering
TEASER op de VSBI Ledenvergadering
TEASER op de VSBI (Vereniging van Saksische Onderwijsinstellingen) Ledenvergadering
Op 10 september 2025 kregen we de kans om het TEASER-project te presenteren tijdens de VSBI-ledenvergadering. Het project onderzoekt het gebruik van AI-aangedreven avatars, die nieuwe vormen van onderwijs en leren mogelijk maken. Ze bieden de mogelijkheid om leerinhoud op een interactieve, gepersonaliseerde en meeslepende manier vorm te geven—een aanpak die bijzonder spannende vooruitzichten biedt voor het beroepsonderwijs.
Onze aanpak wekte veel interesse, vooral in de context van digitalisering en het tekort aan geschoolde arbeidskrachten. Avatars bieden onderwijsinstellingen de kans om hun aanbod toekomstgericht te ontwikkelen en innovatieve leer- en trainingsscenario’s te creëren.
De presentatie van de heer Sam Toorchi Roodsari (PhD-kandidaat aan de TU Dresden) over AI-gebaseerde adaptieve feedback, uitgevoerd in samenwerking met Westermann Verlag, vormde een uitstekende introductie en een thematische brug naar onze TEASER-presentatie.
We waren zeer verheugd onze tussentijdse resultaten te kunnen presenteren tijdens de ledenvergadering—een waardevolle gelegenheid om inzichten in de huidige stand van het project te delen en inspirerende input uit de uitwisseling te ontvangen.


 Gebruik van AI in het Onderwijs bij de Zukunftsdenken.Live Talk
Gebruik van AI in het Onderwijs bij de Zukunftsdenken.Live Talk
Op 7 juni 2024 vond het online evenement “The Future of Work: Achieving Success with AI in the Team” plaats—een gezamenlijk initiatief van Zukunftsdenken.Live en Q4.0 Talk. Het gratis evenement, bijgewoond door ongeveer 50 deelnemers, maakte deel uit van de Nationale Digitale Dag 2024 en werd gemodereerd door Franziska Boy (Regionaal Toekomstcentrum Saksen – MIKOMI).

Een van de experts van de dag was Jens Hofmann, hoofd Digitaliseringsprojecten bij het Saksisch Onderwijsbedrijf voor Milieubescherming en Chemische Beroepen Dresden (SBGDD). In zijn keynote gaf hij fascinerende inzichten in de digitale ondersteuning van onderwijs- en leerprocessen door het gebruik van kunstmatige intelligentie (AI).
Hofmann ging eerst in op de verschillende definities en perspectieven van AI. Hij omschreef het als een hype-tool, een stochastische papegaai, een productiviteitstool, een onderwijs- en leermiddel en zelfs een tijdmachine. Daarnaast besprak hij de verschillen tussen open-source en on-premise oplossingen en liet zien hoe deze effectief kunnen worden ingezet in het onderwijs.

Een bijzonder aandachtspunt van zijn presentatie was het TEASER-project (Teacher as an Avatar), dat het gebruik van AI-aangedreven avatars in het beroepsonderwijs onderzoekt en test. Het project heeft tot doel leraren digitaal te versterken via virtuele avatars, waardoor nieuwe vormen van interactie, ondersteuning en kennisoverdracht mogelijk worden.
Binnen TEASER worden lineaire en niet-lineaire avatars ontwikkeld en geïntegreerd met Learning Management Systems (LMS) voor gebruik in trainingen. Deze avatars kunnen bijvoorbeeld lesinhoud presenteren, vragen beantwoorden of individuele begeleiding bieden aan leerlingen. De aanpak combineert technologische innovatie met didactisch ontwerp, waardoor nieuwe perspectieven ontstaan voor het klaslokaal van de toekomst.
Hofmann benadrukte dat werken met AI een aan te leren vaardigheid is en dat het cruciaal is om zowel leraren als leerlingen in staat te stellen deze nieuwe tools kritisch, creatief en productief te gebruiken.
Het evenement bood deelnemers ook inzicht in verdere praktische voorbeelden uit de industrie, waarmee werd aangetoond hoe de introductie van AI in bedrijven succesvol kan worden geïmplementeerd. De discussies omvatten de noodzakelijke subprocessen voor succesvolle implementatie en het gebruik van AI voor bijscholing in verschillende sectoren.
Toegang tot de volledige lezing hier: The Future of Work: Achieving Success with AI in the Team
WP2 Didactische Richtlijnen / Strategiegids & Roadmaps
Didactische Richtlijnen

Onze nieuwe pedagogische richtlijnen bieden goed onderbouwde benaderingen voor het educatief zinvol en ethisch verantwoord gebruik van AI en avatars in modern beroepsonderwijs.
U kunt de volledige gids met alle details over methoden en praktische toepassingen bekijken door op de afbeelding te klikken om het PDF-document te openen.
Strategiegids

Onze nieuwe strategiegids voor besluitvormers biedt praktische richtlijnen om het proces van digitale transformatie met AI en avatars succesvol te verankeren in uw onderwijsinstelling.
Klik eenvoudig op de afbeelding om de volledige gids als PDF te openen.
Roadmaps

Onze recent vrijgegeven roadmaps bieden gedetailleerde strategieën voor de succesvolle integratie van AI en avatars in verschillende vakgebieden van het beroepsonderwijs.
Klik eenvoudig op de afbeelding om de volledige gids over digitale transformatie als PDF te openen.
Onderwijs- en Leerscenario’s
Leerscenario 1 / Biologie – Inleiding tot celkweek en onderhoud van cellijnen
 Biologie Leer Video – Definitie: Ontdooien en Uitplanten van L929-cellen
Biologie Leer Video – Definitie: Ontdooien en Uitplanten van L929-cellen
In deze video leer je eerst wat de L-929-celijn is en welke kenmerken deze definiëren.
Vervolgens laat ik je stap voor stap zien hoe je pas geleverde L-929-cellen kunt ontdooien en uitplanten.
Je leert waar je op moet letten bij het omgaan met bevroren celculturen en hoe je de cellen optimaal voorbereidt voor verdere groei.
Laten we nu bekijken hoe je veilig en efficiënt met de L-929-celijn kunt werken.
Click here for the video

 Biologie Leer Video – Veilig Werken bij de Laminaire Stroomkast
Biologie Leer Video – Veilig Werken bij de Laminaire Stroomkast
Deze leervideo toont het onderwijzen van veiligheidsregels voor het werken met laminaire stroomkasten.
Click here for the video

 Biologie Leer Video – Veilig Werken met de Autoclaaf
Biologie Leer Video – Veilig Werken met de Autoclaaf
De video belicht ons biologische laboratoriumscenario, met een speciale focus op het onderwijzen van de veiligheidsregels voor het werken met de autoclaaf.
Click here for the video

 Biologie Leer Video – Subcultiveren van de L-929-celijn
Biologie Leer Video – Subcultiveren van de L-929-celijn
In deze video leer je stap voor stap hoe je de L-929-celijn subcultiveert.
Eerst zie je hoe je de werkruimte en materialen onder de laminaire stroomkast voorbereidt.
Vervolgens toont de video hoe je het oude medium verwijdert en de cellen met PBS wast.
Daarna volgt trypsinisatie en een morfologische controle onder de microscoop, voordat de trypsine wordt geneutraliseerd en de cellen worden gecentrifugeerd.
In het volgende gedeelte leer je hoe je het trypsine-bevattende medium verwijdert, vers medium toevoegt en de kweekflessen vult tot een totaal van vijf milliliter.
Tot slot behandelt de video het opslaan van de cellen na subcultivering, een nieuwe morfologische controle en de uiteindelijke schoonmaakprocedures onder de laminaire stroomkast.
Click here for the video

 Biologie Leer Video – Medium Verversen en Cel Telling
Biologie Leer Video – Medium Verversen en Cel Telling
Deze leervideo demonstreert en legt uit hoe cellen worden geteld met behulp van het Neubauer-telkamer.
Je ziet hoe een mediumverversing wordt uitgevoerd voordat de telling plaatsvindt en hoe de cellen worden voorbereid voor analyse.
Click here for the video
Leerscenario 2 / Biologie – Biomaterialen en 3D-bioprinten in Celkweek
 Biologie Leer Video – Voorbereiding van Alginaatinkt
Biologie Leer Video – Voorbereiding van Alginaatinkt
In de volgende leervideo worden eerst de apparatuur en chemicaliën voor het bereiden van alginaatinkt geïntroduceerd.
Vervolgens wordt stap voor stap uitgelegd hoe de alginaatinkt wordt bereid.
Click here for the video
 Biologie Leer Video – Voorbereiding van Gelatinesuspensie
Biologie Leer Video – Voorbereiding van Gelatinesuspensie
In de volgende videotutorial worden eerst de apparatuur en chemicaliën voor het bereiden van een gelatinesuspensie geïntroduceerd.
Vervolgens wordt stap voor stap uitgelegd hoe de gelatinesuspensie wordt bereid.
Click here for the video

 Biologie Leer Video – Voorbereiding en 3D-bioprinten
Biologie Leer Video – Voorbereiding en 3D-bioprinten
In deze leervideo leer je hoe je de gelatinesuspensie en alginaatinkt voorbereidt en welke instellingen op de 3D-bioprinter moeten worden gedaan.
Tot slot wordt het 3D-printproces gedemonstreerd.
Click here for the video
Biologie Leer Video – Hydrogelmodificatie en Herkweek
Biologie Leer Video – Hydrogelmodificatie en Herkweek
Welkom bij onze pilot-test!
In deze video zie je het eerste experiment van het uitplanten van L929-cellen op alginaatobjecten. Het doel is om te bepalen of cellen kunnen groeien op een 3D-geprint alginaatobject.
Er werden drie varianten getest: alginaat behandeld met poly-L-lysine, met collageen en onbehandeld. Na incubatie werden de cellen op de respectieve monsters aangebracht om verschillen in celgroei te observeren.
Aan het einde van de video is er een korte evaluatie die laat zien hoe de herkweek er visueel uitzag bij de verschillende modificaties.
Click here for the video

Leerscenario 3 / Chemie – Visualisatie van de LC2030
 Chemie Leer Video – Visualisatie van de LC2030
Chemie Leer Video – Visualisatie van de LC2030
Deze leervideo behandelt de basisprincipes van regel- en besturingstechniek, specifiek voor de visualisatie van het LC2030-trainingssysteem.
Click here for the video

Leerscenario 4 / Chemie – Driepuntskalibratie op de LC2030
 Chemie Leer Video – Driepuntskalibratie van de LC2030
Chemie Leer Video – Driepuntskalibratie van de LC2030
Deze leervideo behandelt de basisprincipes van regel- en besturingstechniek, specifiek voor de driepuntskalibratie van het LC2030-trainingssysteem.
Click here for the video

Leerscenario 5 / Cybersecurity beheersen
 Phishing en malware opsporen
Phishing en malware opsporen
Welkom op een reis door de wilde, continu veranderende wereld van het internet en cybersecurity. Wist je dat cyberdreigingen vaker voorkomen dan je denkt? Elke dag worden talloze mensen slachtoffer van online oplichting. Laten we deze verborgen gevaren verkennen en leren hoe we onszelf kunnen beschermen.
Click here for the video
 Begrijpen en herkennen van cyberdreigingen
Begrijpen en herkennen van cyberdreigingen
Welkom bij "Begrijpen en herkennen van cyberdreigingen" op je reis om cybersecurity te leren! We zullen echte dreigingen verkennen, zoals malware en phishing – en leren de waarschuwingssignalen op tijd te herkennen. Je zult ook oefenen met communiceren met ChatGPT alsof je een cybersecurityonderzoeker bent! We zullen twee veelvoorkomende soorten cyberdreigingen leren identificeren: malware en phishing. Ik zal je voor elk een echt voorbeeld laten zien, en daarna gaan we samen naar ChatGPT en leren hoe we de juiste vragen kunnen stellen.
Click here for the video
 Worden we aangevallen?!
Worden we aangevallen?!
Leerlingen passen toe wat ze hebben geleerd door een realistisch scenario van een cyberdreiging te analyseren, met ChatGPT te communiceren voor advies en hun acties te rechtvaardigen in een groepsdiscussie. Je hebt al geleerd om dreigingen zoals phishing en malware te herkennen. Nu is het tijd om je kennis toe te passen in een echte situatie. Je zult opnieuw met ChatGPT communiceren, zoals eerder, maar deze keer moet je je denkwijze uitleggen en beslissingen nemen. Laten we deze cyberinstincten testen!
Click here for the video
Leerscenario 6 / Basisprincipes van Python met Avatar
 Ontgrendel de kracht van Python: jouw eerste stappen in programmeren
Ontgrendel de kracht van Python: jouw eerste stappen in programmeren
Ben je nieuw in programmeren? Wil je Python leren met een futuristische twist? Dan ben je op de juiste plek! Onze interactieve programmeercursus begeleidt je door de basis van Python-programmering, ondersteund door door AI gegenereerde avatars en realtime hulp van ChatGPT.
Click here for the video
 Python-functies en basis van syntaxis
Python-functies en basis van syntaxis
Laten we een korte blik werpen op hoe Python werkt – en geloof me, het is makkelijker dan je denkt.
Click here for the video
Leerscenario 7 / Professionele communicatie – Feedback via gesimuleerde dialoog (Mevrouw De Vries)
 Professionele communicatie – Feedback via gesimuleerde dialoog
Professionele communicatie – Feedback via gesimuleerde dialoog
Als onderdeel van het Erasmus+ TEASER-project is Mevrouw De Vries ontwikkeld als een door AI aangedreven avatar, die MBO/VET-studenten in staat stelt professionele communicatie- en feedbackvaardigheden te oefenen in een realistische, WhatsApp-achtige chatomgeving. Het leerscenario is stevig verankerd in het 4G-feedbackmodel (Gedrag, Gevoel, Gevolg, Gewenst Gedrag) en volgt een gestructureerde pedagogische volgorde bestaande uit introductie, uitvoering, reflectie en afsluiting.
Click here for the video
Leerscenario 8 / Sociaal werk (Moeder Jarno)
 Sociaal werk (Moeder Jarno)
Sociaal werk (Moeder Jarno)
In deze leereenheid oefenen cursisten met het professioneel omgaan met moeilijke gesprekken met cliënten in een veilige, digitale omgeving. De kern van het scenario omvat een confrontatie met een verontruste moeder die, wanneer ze haar kind (Jarno) uit de kinderopvang haalt, ontdekt dat het kind is gebeten zonder dat zij van tevoren geïnformeerd was. De leerlingen communiceren met een door AI aangedreven avatar om de-escalatietechnieken toe te passen, empathie te tonen en de situatie professioneel te behandelen.
Click here for the video
Leerscenario 9 / Interactieve avatar voor veiligheid in de klas
 Interactieve avatar voor veiligheid in de klas – CNC-machine
Interactieve avatar voor veiligheid in de klas – CNC-machine
Kerninhoud: Instructies voor het dragen van persoonlijke beschermingsmiddelen (veiligheidsbril, gehoorbescherming, veiligheidsschoenen).
Click here for the video
 Interactieve avatar voor veiligheid in de klas – Elektrisch
Interactieve avatar voor veiligheid in de klas – Elektrisch
Kerninhoud: Waarschuwing om niet te werken met natte handen of in een vochtige omgeving.
Click here for the video
 Interactieve avatar voor veiligheid in de klas – Fablab
Interactieve avatar voor veiligheid in de klas – Fablab
Kerninhoud: Algemeen respectvol omgaan met apparatuur.
Click here for the video
 Interactieve avatar voor veiligheid in de klas – Fotolab
Interactieve avatar voor veiligheid in de klas – Fotolab
Veilig omgaan met camera’s en lenzen: Zorg er altijd voor dat ze veilig zijn bevestigd, stabiel geplaatst en voorzichtig behandeld worden.
Click here for the video
Leerscenario 10 / Teaser AI-assistent
 Teaser AI assistant
Teaser AI assistant
Dit scenario presenteert een intelligente, op GPT gebaseerde assistent die leraren helpt hun lessen te evalueren volgens pedagogische best practices en het kader voor digitale competenties DigComp 2.2. De assistent voert een gestructureerde beoordeling van lesplannen uit, identificeert ontbrekende elementen, geeft suggesties voor verbetering en simuleert het denken van een expert. Leraren communiceren met de GPT-evaluator via begeleide gesprekken, gestructureerde invoer en voorbeelden op basis van feedback. Het systeem maakt snellere, consistenter en kwalitatief hoogwaardigere evaluaties mogelijk, vooral voor nieuwe leraren of degenen die betrokken zijn bij digitale transformatieprojecten.
WP4 Blended Learning Cursus
Blended Learning Cursus

Onze blended learning cursus “Avatar.AI course” biedt basiskennis over AI en avatars, hun toepassing in beroepsonderwijs, veiligheids- en ethische overwegingen, evenals de pedagogische meerwaarde van avatars.
Na het klikken op de cursusknop wordt u doorgestuurd naar Moodle, waar u kunt inloggen of registreren en de cursus kunt volgen in het Duits, Grieks, Nederlands, Sloveens of Engels. Na het voltooien van de evaluatie ontvangt u een certificaat (badge).
Wachtwoord voor de cursus: teaser
WP5 Promotionele activiteiten
Podcasts
Best Practice Gids

Gebruik onze Best Practice Guide als praktische “handleiding” en waardevolle kompas om digitale transformatie met AI en avatars succesvol in uw opleidingsprogramma’s te verankeren.
specialist article (Vakartikel)

Ons project introduceert een mensgerichte “Digitale Pedagogiek” die technologische innovaties zoals AI en avatars gebruikt als digitale assistenten om menselijke onderwijsexpertise te versterken in plaats van te vervangen. Volgens het principe “Pedagogiek vóór Technologie” stellen we docenten in staat zich te ontwikkelen van passieve gebruikers tot actieve vormgevers van digitale transformatie in het beroepsonderwijs. Lees in het volledige artikel meer over de wetenschappelijke begeleiding, het overwinnen van de “Turing-val” en de empirisch bewezen efficiëntiewinsten van ons model.
Innovation Digest – 8 impulsen voor digitale transformatie

Ontdek in onze Innovation Digest de meest spannende hoogtepunten en trends rond het gebruik van AI en avatars in het beroepsonderwijs. Laat u inspireren door praktische inzichten en kom beknopt te weten hoe u digitale transformatie in uw opleiding succesvol kunt bevorderen.
Projectduur:
10/23-12/25
Projectpartners:


![]()










































In this learning unit, trainees practice handling difficult client conversations professionally in a safe, digital environment. The core of the scenario involves confrontation with an upset mother who, when picking up her child (Jarno) from a daycare, discovers that the child has been bitten without being informed beforehand. Learners interact with an AI-driven avatar to apply de-escalation techniques, show empathy, and handle the situation professionally.
Click here for the video